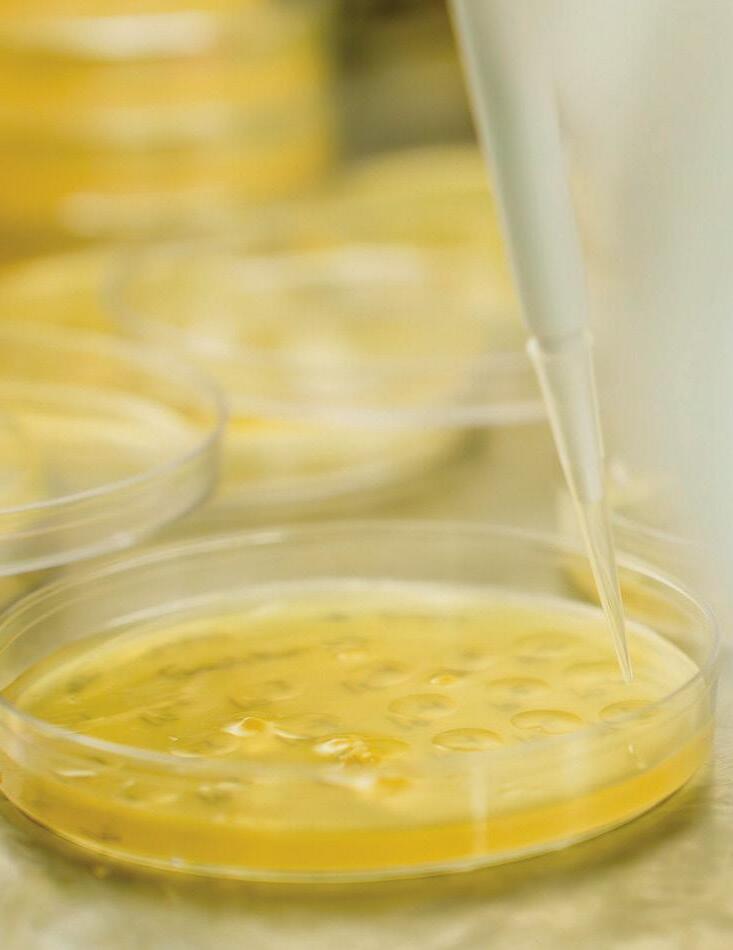
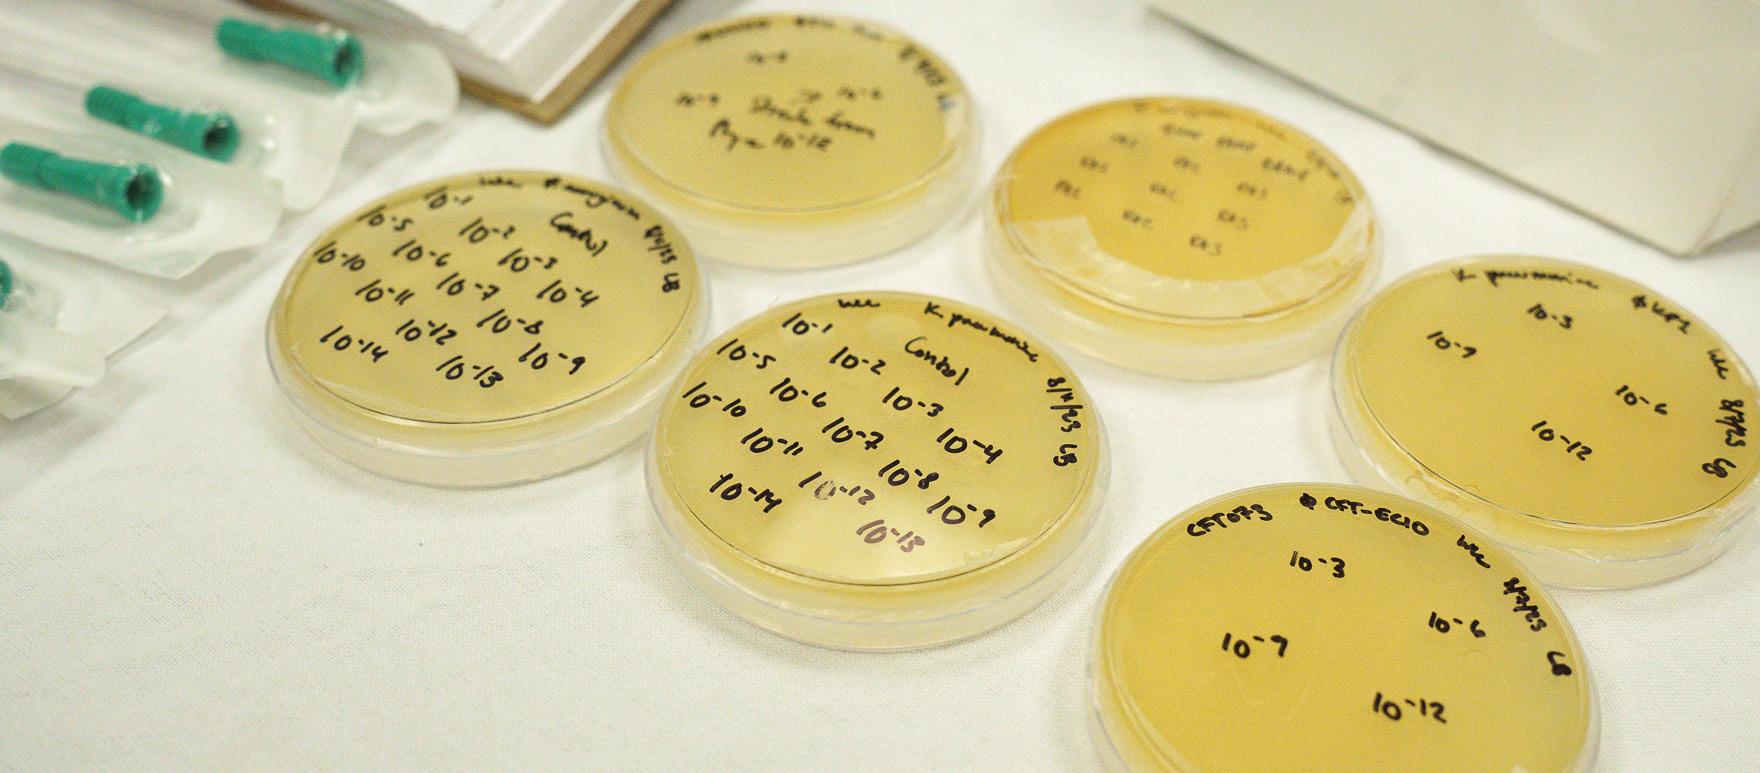

![]()









The OSU College of Osteopathic Medicine at the Cherokee Nation is changing lives and helping to improve health outcomes in tribal and underserved communities. Pages 62-69 (Cover photo: Gary Lawson | NOTE: The background text is the Osteopathic Oath in Cherokee)
The first graduating class at the Cherokee Nation campus in Tahlequah celebrates historic graduation milestone.
OSU College of Medicine provides different tracks to best serve and empower students.
OSU Foundation hosts Women for OSU Symposium, honors Clerico as Philanthropist of the Year.
Two OSU alumni make their mark in the CIA and SEAL Team Six, respectively.
OSU Tactical Fitness and Nutrition Lab aids first responders in staying healthy despite stressful careers.

The Oklahoma Aerospace Institute for Research and Education explores new ways to study weather and aid in disaster recovery.

The OSU Museum of Art celebrates a decade of campus and community enrichment.
Alumna creates nonprofit that donates shoes to children in need.

Megan Horton | Interim Associate Vice President of Brand Management
Lance Latham | Chief Communications Officer
Erin Petrotta | Director of Marketing
Shannon Rigsby | Associate Director of Public Information
Mack Burke | Associate Director of Media Relations
Casey Cleary | Associate Director of Marketing Strategy
Jeremy Davis | Associate Director of Multimedia
Dave Malec | Design Coordinator
Jordan Bishop | Managing Editor
Codee Classen, Cody Giles and Stephen Matthews | Design
Phil Gahagans and Karolyn Moberly | Advertising
Gary Lawson, Ellie Piper and Elizabeth Rogers | Photography
McKinzie McElroy | Inside OSU
Kurtis Mason | Trademarks and Licensing
Kinsey Garcia and Kara Peters | Administrative Support
Contributors: Elizabeth Gosney, Samantha Hardy, Hallie Hart, Jeff Hopper, Stephen Howard, Desa James, Page Mindedahl, David Peters, Sara Plummer, Grant Ramirez, Jillian Remington, Shannon Rigsby, Sydney Trainor and Mak Vandruff
Department of Brand Management | 305 Whitehurst, Stillwater, OK 74078-1024 405-744-6262 | okstate.edu | statemagazine.okstate.edu | editor@okstate.edu | osu.advertising@okstate.edu
OSU ALUMNI ASSOCIATION
Kurt Carter | Chair
Scott Eisenhauer | Vice Chair
Tina Parkhill | Immediate Past Chair
Dr. Ann Caine | President
Jake Wilkins | Vice President of Business Development
David Parrack | Vice President of Finance and Operations
Thomas Blalock, Zach Burrow, Susan Crenshaw,Benjamin Davis, Deedra Determan, Jonathan Dodson, Sonja Hughes, Ginger Kollmann, Brian Krafft, Chris Moody, Aaron Owen, Joe Ray, Darin Schmidt, Taylor Shinn, Baloo Subramaniam, Matt Waits, Susanne Wasson and Cecilia Robinson Woods | Board of Directors
Will Carr, Chase Carter, Katie Dragoo, Bailee Kirby, Jillian Remington and Madelyn Trentham | Marketing and Communications
OSU Alumni Association | 201 ConocoPhillips OSU Alumni Center, Stillwater, OK 74078 | 405-744-5368 | orangeconnection.org | info@orangeconnection.org
OSU FOUNDATION
Bill Patterson | Chair
Blaire Atkinson | President
Robyn Baker | Vice President and General Counsel
Dawn Barnard | Vice President and Chief Financial Officer
Scott Roberts | Vice President of Development
Pam Guthrie | Senior Associate Vice President of Human Resources
Blaire Atkinson, Bryan Begley, Ann Caine, Brian Callahan, Bryan Close, Ann Dyer, Jennifer Grigsby, David Houston, Brett Jameson, Griff Jones, Robert Keating, Shelly Lambertz, Greg Massey, Ross McKnight, Gail Muncrief, Bill Patterson, Jenelle Schatz, Terry Stewart, Beverly Walker-Griffea, Jay Wiese and Darton Zink | Trustees
Demetri Cruse, Bryanna Freer, Samantha Hardy, Jennifer Kinnard, Chris Lewis, Estefania Martinez-Vazquez, Amanda Mason, Heather Millermon, Michael Molholt, Grant Ramirez and Benton Rudd | Marketing
OSU Foundation | 400 South Monroe, P.O. Box 1749, Stillwater, OK 74076-1749 800-6224678 | OSUgiving.com | info@OSUgiving.com
STATE magazine is published three times a year (fall, winter, spring) by Oklahoma State University, 305 Whitehurst, Stillwater, OK 74078. The magazine is produced by the Department of Brand Management, the OSU Alumni Association and the OSU Foundation, and is mailed to current members of the OSU Alumni Association. Magazine subscriptions are available only by membership in the OSU Alumni Association. Membership cost is $50. Call 405-744-5368 or mail a check to 201 ConocoPhillips OSU Alumni Center, Stillwater, OK 74078-7043. To change a mailing address, visit orangeconnection.org/update or call 405-744-5368.
Oklahoma State University, as an equal opportunity employer, complies with all applicable federal and state laws regarding non-discrimination and affirmative action. OSU is committed to a policy of equal opportunity for all individuals and does not discriminate based on race, religion, age, sex, color, national origin, marital status, sexual orientation, gender identity/ expression, disability, or veteran status with regard to employment, educational programs and activities, and/or admissions. For more information, the director of equal opportunity/Title IX coordinator is located at 401 General Academic Building and can be reached at 405-744-1156 or by visiting https://eeo.okstate.edu.
This publication, issued by Oklahoma State University was printed by Slate Group at a cost of $1.39 per issue: 35,729 | August 2024 | #statefall24 | Copyright © 2024, STATE magazine. All rights reserved.

In the fall of 2020, in the midst of a historic pandemic, the first class of the OSU College of Osteopathic Medicine at the Cherokee Nation was making history of its own. This spring, 46 medical students from the inaugural class added the perfect bookend to their momentous beginning with a graduation celebration for the nation’s first tribally affiliated medical school.
In this issue, we commemorate that milestone (Page 62) and explore how OSU is working to make a difference in tribal and underserved communities (Page 67), filling the pipeline of rural physicians and advancing health outcomes across the state.
This year also marks the 10th anniversary of the OSU Museum of Art, which opened in 2014 with significant support from then president Burns Hargis and First Cowgirl Ann Hargis, as well as visionary donors such as Bill Goldston and Malinda Berry Fischer. The museum continues to elevate OSU’s visual arts programs and the Stillwater community through collaborative arts programming (Page 54).
The OSU Foundation’s Women for OSU Symposium recently honored Cheryl Clerico, who, along with her husband, John, have committed more than $16 million to OSU, including nearly $5 million to the Clerico Family Foundation Scholarship (Page 14).
Learn more about how OSU’s Tactical Fitness and Nutrition Lab is providing impactful wellness resources for the nation’s first responders (Page 38) and how the Oklahoma Aerospace Institute for Research and Education is pursuing groundbreaking research aimed at better understanding and responding to severe storms (Page 46).
We also dive into exciting stories about how alumni continue to live out the land-grant mission long after graduation — either as operatives advancing national security (Page 24) or the founder of a nonprofit that’s making a real difference in the lives of young athletes (Page 58).
The Department of Philosophy has received the largest gift in department history — one of the 10 largest ever made to any higher education philosophy program — thanks to a $6.75 million gift from donors Dennis Heinzig and Iona McMillan aimed at advancing ethics and critical thinking (Page 86).
It’s always a great time to be a Cowboy, but the fall semester has an added layer of optimism and excitement, and as I enter my sixth year at the helm of STATE magazine, I can’t help but marvel at the progress that’s taken place over the last half-decade and all that’s to come.
Go Pokes!
Mack Burke Editor













At O kla hom a State U niversit y, we a ren’ t waiting for a bet ter world — we’re b uilding it . Pu s hing past t he im pos sible, OSU is em b racing a bold vision a n d b rea king new g roun d in teaching , resea rch a n d E x ten sion .
By making access to education a priorit y, we are breaking down barriers and providing a welcoming environment where ever y student is prepared to lead and thrive in a global societ y
A s leaders in research , we are innovating solutions to the world ’s most pressing problems With a focus on collaboration across disciplines , OSU researchers embody the spirit of exploration and cultivate cut ting-edge break throughs .
Through our E x tension programs , OSU is making a transformational impac t that reaches across all of Oklahoma Going beyond our campus to local, state and global communities , we are prompting positive change through the power of connec tion
When I was president of the OSU Center for Health Sciences, I had the very good fortune to meet Cherokee Nation Principal Chief Bill John Baker. In one of our first conversations, he shared with me that Cherokee culture focuses on doing things that can make a difference for seven generations to come — 140 years.
This made an incredible impression on me and, combined with OSU’s mission to deliver better health outcomes for Oklahomans, led to an incredible partnership and the creation of the nation’s first tribally affiliated medical school — the OSU College of Osteopathic Medicine at the Cherokee Nation.
The school opened in 2020, and today, students from 11 different tribes and 46 counties in Oklahoma study and provide rural health care to patients at the campus in Tahlequah. It was a great honor to celebrate the commencement of our inaugural class of physicians in May. I am so proud of their dedication to their profession, their communities and the land-grant mission that calls us to leave a lasting, positive impact on the world. Our graduates are leading the way for those who will follow for seven generations and beyond. Through all of our graduates, our programs and our commitment to addressing major societal challenges, OSU is leading the way in Oklahoma. We’re uplifting communities, bolstering the state’s economy and empowering graduates with the in-demand skills and values that will open doors of opportunity to fulfilling and meaningful careers.

To help increase and sustain our impact on the state of Oklahoma, the OSU/A&M Board of Regents recently voted to keep tuition and mandatory fees flat for the third straight year. I applauded their vision and commitment to prioritizing student access and affordability while continuing to expand the reach and impact of Oklahoma’s largest university system. Eliminating or reducing student debt is a key imperative in our strategic plan, as is expanding student scholarships.
From the OSU Polytech initiative, to exciting advances being developed at our applied research institutes, The Innovation Foundation and across the entire OSU System, we have immense momentum going into the fall semester. I’m thankful for everyone in the Cowboy family — our faculty, staff, students and alumni — for their crucial and ongoing contributions to our beloved university and the land-grant mission we proudly serve.
Go Pokes!
Dr. Kayse Shrum OSU President osupres@okstate.edu
Adigital humanist and early modernist with a Ph.D. in romance languages from the University of Georgia, Dr. Melinda Cro became the first female dean of Oklahoma State University’s College of Arts and Sciences in July. With 15 years of higher-ed teaching and administrative experience — most recently at Kansas State University — Cro now leads OSU’s largest college, which includes 24 departments, 650 faculty, 200 staff and nearly 7,000 students. Cro recently discussed her vision for the college with STATE magazine as she embarks on this new role.
What were some of your first impressions of CAS?
CAS is an incredibly special place, one where the promise of the land-grant institution is fully realized. I recognized that the moment I met with the dean search committee, made up of faculty across the college who were engaged, friendly and a true testament to the ethos of the servant-leader that embodies Oklahoma State’s values. It was further cemented when I visited with Provost Jeanette Mendez, President Kayse Shrum and the campus community, including amazing CAS student representatives.
The students were engaged, sharing how their experiences in CAS had shaped them. Each of them evinced the Cowboy Code as we talked about how to support students into the future. CAS brings together a diverse group of people around a shared set of values centering on inclusive collaboration, engagement, and the generation of and access to knowledge focused on improving our communities. I am thrilled to support students, faculty and staff in realizing our mission to become the preeminent landgrant college of arts and sciences in alignment with the university’s strategic plan.
How do you see CAS positioning itself within the We Are Land-Grant plan?
This past year, CAS faculty and staff collaborated with leadership to develop the college strategic plan that firmly centers the arts and sciences at the heart of the land-grant institution. The university plan leverages OSU’s strengths to address grand challenges. Similarly, our college plan harnesses inherent CAS strengths to prioritize student success, broadly and holistically defined, through dedicated faculty and staff; develop innovative curricula and foundational courses that engage learners in transdisciplinary modes to face the challenges of an increasingly globalized world; advance the research enterprise through increased focus on extramural funding, early career awards, external outreach about our research and an emphasis on transdisciplinary work; and build on the Extension work we are already undertaking to engage more fully with our community.


The We Are Land-Grant plan asks each member of the institution to think about how we can improve and contribute to our community. CAS will serve a critical role in that work by leveraging our resources to build up college readiness across the state, reducing the cost of college while enhancing access; developing ideal graduates positioned to succeed in the workforce of tomorrow; and advancing transdisciplinary research to expand our understanding of the world while designing solutions to our most pressing challenges.
How is CAS helping solve societal challenges?
The beauty of CAS is our three pillars: arts and humanities, social sciences, and math and sciences. If we stay within our pillar area, you can get depth potentially, but we’re missing out on the transdisciplinary reality of research and problem-solving.
The big challenges that we face as a society require a multi-pronged approach. If we’re not thinking about the full reality of the human experience as we’re looking at a problem, it will be very difficult to provide a holistic or effective solution. That’s what the land-grant is all about: leveraging our strengths and bringing together our expertise in applied, meaningful ways that will help to make a difference in this world for the better.
How can OSU capitalize on the expansive expertise within CAS?
There is strength in diversity of thought and perspective, and that’s what CAS has. Even though an experience in chemistry is going to be different from an experience in modern languages, we come into the room with shared values.
I love President Shrum’s focus on ways that the university can leverage its comprehensive resources in a meaningful push toward solving grand challenges because those things are only achievable with the full breadth of the university’s resources, including CAS. For any challenge we face, the solution will require the collaboration of groups to understand the context and the human impact. When we’re talking about societies and cultures, you need all CAS areas to solve the problem. We are stronger together than we are apart.
Dr. Hanchen Huang comes to CEAT with an impressive repertoire of leadership and academic accomplishments.
Previously provost and vice chancellor for academic affairs at the University of Massachusetts-Dartmouth and dean of the College of Engineering at the University of North Texas, Huang has been dean of CEAT since April. STATE magazine sat down with Huang to discuss his view of the college’s role in the landgrant landscape.
CEAT encourages interdisciplinary research. How do you believe this can benefit future architects and engineers?
The word “interdisciplinary” is intrinsic to CEAT and characteristic of my educational background, work experience and research. CEAT supports collaborative research and education in engineering, architecture, technology and agriculture. Working with my students and associates, we have crossed multiple disciplinary boundaries — from the discovery of physics that makes nanorods nano in scale, to the invention of metallic glue technology, and to commercialization of this technology through our startup company.
Would you consider your research expertise to be in nuclear or overall mechanical engineering?
While I teach mechanical engineering, my research is in the areas of materials and energy, and my education is in physics and nuclear engineering. Our primary contribution is in the area of nanorods synthesis and mechanics — from atomistic simulations to theories and experiments.
Speaking of research, what are some emerging areas of research grabbing your attention?
At the national level, the synergy of artificial intelligence with engineering represents an umbrella of emerging areas of research. Our report “Additive Manufacturing Trends: Artificial Intelligence Machine Learning” in Advance Materials & Processing 178 (5), 32-33 (2020), for example, summarizes the synergy of artificial intelligence and manufacturing.
Closer to home at OSU, two other areas could emerge based on our core competencies. Energy science and technology can be an area that builds on the existing strength of our Hamm Institute for American Energy. Manufacturing engineering of agriculture products can be another area that integrates the A and M in our system name, OSU A&M.
Why are CEAT students and graduates so important to the Oklahoma workforce?
With about 3,000 job openings in engineering and technology and 1,500 graduates each year in Oklahoma, OSU, as a land-grant university, has an obligation to graduate more engineers and technologists. Being the M in OSU A&M, engineering (as well as architecture and technology) is in the DNA of OSU. The education of students and professionals through CEAT at OSU, a top-tier (R1) university, is forward-looking and meets society’s needs now and in the future.


How can CEAT assist Oklahoma and society as a whole in the following priority areas?
1. Innovating to Nourish the World
2. Leading in Aerospace Innovation and Application
3. Enhancing Human and Animal Health (One Health)
4. Powering a Growing World Population Sustainably and Responsibly
CEAT is so well positioned in all four areas. In particular, CEAT is a leader in aerospace development and applications as well as in innovation and has the technical expertise to lead energy research and education for a sustainable world. Further, with expertise in bioengineering and engineering analytics, CEAT is in a great position to collaborate with health sciences to enhance human and animal health. Overall, our strategy is to raise the standing of engineering, architecture and technology to elevate OSU.
With a goal of faculty recruitment and retention, what changes would you like to see within CEAT and OSU?
One, I would like to promote preemptive retention and develop a stronger sense of faculty and staff belonging through engagement among faculty and staff. Two, I would like to promote proactive recruiting to form clusters of wellestablished faculties.
Dr. Melanie Morgan started as the new Oklahoma State University Graduate College dean in July.
Morgan has served as professor and associate dean of the Graduate School at Purdue University since 2018.
She also previously served Purdue as director of Graduate Studies in the Brian Lamb School of Communication (2014-18) and director of the Oral Communication Curriculum Program (2001-18) and held a previous appointment as an assistant professor in the Department of Communication at the University of Louisville (1998-2001).
Morgan discussed her new role with STATE magazine.
How is OSU’s Graduate College working to elevate the land-grant mission as a university?
I was attracted to the opportunity to lead the Graduate College at Oklahoma State because of the strategic vision emphasizing the landgrant mission. The Graduate College is working to enhance this mission in several ways. First, the college is participating in a National Science Foundation Grant, “Broadening Participation in STEM Graduate Degrees.” This award will refine and improve the ways we recruit students to graduate programs, increasing access to programs. Second, the Graduate College is engaged in a national workforce development program, Accelerate to Industry (A2i), which works with industry partners in Oklahoma to prepare graduate students and postdocs for industry positions after graduation. This program builds upon the Graduate College’s 360˚ Critical Skills for Career Success Professional Development Program to ensure graduates are industry ready. Additionally, new articulation agreements with Stillwater and Tulsa will provide access to accelerated master’s degrees, dual degrees, and Professional Science Master’s degrees helping to prepare our future workforce here in the state.
What are some opportunities for growth in OSU’s Graduate College?
One tenant of the land-grant mission that I fully support and embrace is access. While OSU already provides opportunities for its students to participate in graduate education, there are additional and creative ways to make graduate education even more accessible. I’d like to explore these and build upon them so that postgraduate opportunities are available to everyone.
Creative interdisciplinary degrees, dual degrees, and other types of credentialling provide additional opportunities for graduate students to build successful research programs and equip them with the skills to solve complex problems. OSU has recently expanded these opportunities, and I’d like to see these continue to grow and flourish.
Graduate school is a rigorous experience requiring students to persevere during some challenging moments. OSU has some terrific support mechanisms in place to help graduate students succeed and we can build on these programs to make sure students are wellsupported during their graduate school experience so that we can attract and retain the best students.

What role does the Graduate College play for OSU and its students?
The Graduate College is the voice and the advocate for graduate education. Most of the attention and resources at universities like OSU are undergraduate-focused and the graduate perspective is sometimes secondary. The Graduate College has an important role to ensure that the graduate experience does not get lost and best practices are being followed across campus.
The Graduate College is the administrative center for graduate student education. We admit students and support them on their journey through graduation. We support the day-to-day functioning of the graduate school experience and make sure students get registered, are on track and graduate on time.
How does the OSU Graduate College prepare students to become ideal graduates?
While the Graduate College does many things to help prepare students to become ideal graduates, I’d like to focus on 360° Critical Skills for Career Success. This program goes beyond the technical and discipline-specific knowledge a graduate student learns in the home department to prepare them for success after graduate school. Students can choose training across six skill areas including research, communication, teaching, leadership, management and leadership. Through workshops and hands-on experiences, students work to build competencies in these areas. These skills equip our students to serve their communities with compassion and make important impacts in their lives and in others.
What are some of your passions and how do you plan to incorporate those into the OSU Graduate College?
One of my passions is graduate student mentoring. Graduate education is built on an apprentice model where a seasoned faculty member mentors an emerging scholar to develop the student’s research expertise. The mentoring relationship between a faculty member and a student is an important one. The quality of the mentoring relationship is a strong predictor of student success in graduate school. However, mentoring in a one-on-one relational model can often be tricky. Faculty and graduate students need resources to excel in these roles and I plan to build on the resources already established at OSU to enhance mentoring training programs and resources to assist faculty and graduate students in navigating this important relationship.
I am also passionate about opportunities for graduate students to expand their skill sets and engage in impactful research. Graduate students are the engine that powers our research mission at an institution like Oklahoma State. The more opportunities and the better-resourced graduate students are, the more they can accomplish to move our research agenda forward. I aim to partner with the Division of the Vice President for Research and the academic colleges to create more opportunities for graduate student research and avenues to showcase their contribution to the research mission.

hrough her passion for supporting Oklahoma State University, Cheryl Clerico hopes to inspire a new wave of philanthropic Cowboys.
On April 25, Clerico was honored as the 2024 Women of OSU Philanthropist of the Year at the annual Women for OSU Symposium inside Gallagher-Iba Arena. This prestigious recognition celebrates Clerico’s enduring support for OSU and honors philanthropy within the Cowboy family.
For over 15 years, Women for OSU has played a pivotal role in advancing the university’s mission by celebrating philanthropy and the financial contributions of its council and the broader OSU community.
Clerico, along with her husband, John, have committed more than $16 million to OSU, with nearly $5 million funding the Clerico Family Foundation Scholarship, which goes beyond financial aid. The Clerico family — Cheryl, John, and their daughter, Diane Deakin — meet with each scholarship recipient twice a year to offer guidance and work to connect them with people who can help them succeed.
“Giving back is a key element of the Cowboy culture at Oklahoma State,” Clerico said. “Our family receives great joy and satisfaction from the personal growth and the continuing successes of our Clerico Family Foundation scholarship recipients.”
OSU President Kayse Shrum praised the Clericos for their heartfelt contributions and profound impact on OSU.
“It is amazing the amount of time they commit to the [Clerico Family Foundation] scholars,” Dr. Shrum said. “It’s not just a scholarship; it’s an investment in helping individuals reach their goals and becoming the person they have dreamed of being.”
Courtney Neff, an OSU alumna and Clerico scholar, recalls the transformative impact of the Clerico family’s mentorship. Arriving at OSU as an anxious first-generation college student, Neff found the support she needed to succeed through the family’s guidance. Now serving as the Section 106 coordinator for the Osage Nation Historic Preservation, Neff credits the Clericos with helping her achieve her goals.
Longtime “Inside Edition” anchor, a two-time Emmy winner and a New York Times bestselling author Deborah Norville inspires the attendees by sharing how practicing gratitude can impact our lives for the better.
Find your passion, help make dreams a reality. You will be helping future generations of students, and I promise you it will be one of the most rewarding things you will ever do.”
“I received a lot of guidance and mentorship,” Neff said. “The Clericos gave me a lot of confidence in my abilities. We had dinners every fall where we talked one-on-one, and I benefited greatly.”
Inspiration for Cheryl and John’s philanthropy traces back to the legendary OSU philanthropist, T. Boone Pickens.
“He inspired many of us to devote our time and resources to the betterment of Oklahoma State,” Clerico said. “One of Mr. Pickens’ favorite sayings was ‘There are two types of people in this world: givers and takers.’”
Clerico is passionate about passing on this spirit of giving to the next generation. This year, the Women for OSU council awarded 16 scholarships, including the 2024 Student Philanthropist of the Year, Kodie Gough.
“Philanthropy is simply the greatest gift ever,” Gough said. “It is such an honor to be able to serve the Stillwater community. It has given me a sense of purpose within Stillwater instead of simply just being a student.”
A marketing major from Graham, Texas, Gough exemplifies the philanthropic spirit through her involvement with the Cowboy Strong Student Emergency Fund and efforts to combat food insecurity on campus. Her volunteer work extends to organizations such as Our Daily Bread and Big Brothers Big Sisters, and she serves on the Spears School of Business Student Council and the OSU Student Foundation.

Cheryl Clerico


Philanthropy is simply the greatest gift ever. It is such an honor to be able to serve the Stillwater community. It has given me a sense of purpose within Stillwater instead of simply just being a student.”


“Kodie is extremely reliable, and her enthusiasm really carries through for her as the philanthropy chair,” said Sarah Johnson, OSU Spears School of Business assistant dean for undergraduate learning. “Kodie always brings to the table activities that she knows students will be interested in, and she gets the group ready to go in a professional way. She creates an environment that Spears and OSU can be really proud of.”
Like Gough, Clerico encourages the entire OSU family to find their own way to support the university.
“John and I would like to challenge everyone to find a need or a project that can benefit from your time and resources,” she said. “Find your passion, help make dreams a reality. You will be helping future generations of students, and I promise you it will be one of the most rewarding things you will ever do.”
The Women for OSU Partner Program offers the OSU community impactful opportunities to support the university. One of the membership benefits is selecting the Partnering to Impact grant recipients. Partnering to Impact’s mission is to support unbudgeted projects that benefit the health and wellness, education, campus beautification, or arts and culture across the OSU system. Since 2020, the program has funded 20 initiatives.
At this year’s symposium, five projects received Women for OSU Partnering to Impact grants: Increasing Access to Civic Education for Underserved

OSUgiving.com/women/scholars.
Rural Students in Oklahoma, Orofacial Myofunctional Therapy, F1RST2GO, Sonia Kovalevsky Day Math Workshop and Red Pantry Hygiene Expansion.
Jayme Ferrell, OSU Foundation associate vice president of constituent development and previous director of Women for OSU, believes that philanthropy within the Cowboy family transforms lives.
“Cheryl, Kodie and all our student scholars inspire us to support our passions and serve our communities,” Ferrell said. “We are grateful for generations of Cowboys who demonstrate their love for OSU through philanthropy and a culture of giving.”
For more information on becoming a symposium sponsor or to join Partnering to Impact, visit: OSUgiving.com/women

Partnering to Impact has awarded 20 grants to unbudgeted projects across the OSU system since 2020. Members of the OSU family can become a partner by giving a minimum of $1,000 annually to the Partnering to Impact Fund or $500 annually for those who are younger than 35. To join, visit OSUgiving.com/women.
THE 2024 PARTNERING TO IMPACT GRANT RECIPIENTS:
Increasing Access to Civic Education for Underserved Rural Students in Oklahoma
Orofacial Myofunctional Therapy
F1RST2GO
Sonia Kovalevsky Day Math Workshop
Red Pantry Hygiene Expansion

Corporate Presenting Sponsor
THANK YOU TO OUR GENEROUS SPONSORS FOR MAKING THE 2024 WOMEN FOR OSU SYMPOSIUM A REMARKABLE SUCCESS!
Thank you to the Women for OSU council, led by chairwoman Leslie Paris, for their dedication. We are grateful for your commitment to ensure all Women for OSU programs are successful.
Platinum Sponsor
Jimi Davidson
Gold Sponsors
Julie Blanchard and Susan Glasgow
Robin Byford and Becky Steen
Cheryl Clerico
Amy Cline
Kayleen Ferguson
Anne Greenwood
Virginia Hellwege
Joan Hert and Sharon Chaufty
Claudia Humphreys
Jami Longacre
Pam Martin
Lynn McElroy
Amy Mitchell and Vicki Howard
Jennie Moyes
Gail Muncrief
OSU Alumni Association
OSU Athletics
OSU Center for Health Sciences
OSU College of Arts and Sciences
OSU College of Education and Human Sciences
OSU College of Engineering, Architecture and Technology
OSU Division of Agricultural Sciences and Natural Resources
OSU Foundation
OSU Spears School of Business
Jan Polk
Jenelle Schatz
Terry Slagle
JJ Stevak
Stillwater Medical Center
Melinda and Joel Stinnett
Stock Exchange Bank - Sheryl
Benbrook
Lucina Thompson
Michel Thompson
Sharon Trojan and Roxanne Pollard
Denise Weaver
Dava White
Marsha L. Williams
Silver Sponsors
Tammy Bove
Brenda Buck and Tracie Chapman
Kirsten Daniel
Karen Gallagher
Aimee Hale
Ann Halligan
Lynn Hilst
Traci Jensen
Jeanette Kern
Charlotte Pittman
Gwen Shaw
Gina Wilson
Orange Sponsors
Jenny Carter
Renee Ebert
Patricia Hudson
Jeanene Hulsey
Whitney McKellar
Retta Miller
Leslye Trachte
Leslie Woolley
Digital Sponsor

OSU President's Office April 24, 2025 WOMEN FOR OSU SYMPOSIUM
motivational speaker and award-winning humanitarian



Start your game day at the ConocoPhillips OSU Alumni Center!
Enjoy a free, family-friendly pep rally 2 1/2 hours before every home game. Take pictures with Bullet steps away from the Spirit Walk, and grab a game day snack before the game!
Check the day’s scores on surrounding screens, and snap some fun commemorative pics in our photo booth.
Members can enjoy a complimentary Iron Monk beverage or bottled water and pick up limited promo items while supplies last.
Alumni Association members 21 and older can enjoy one complimentary beverage at Iron Monk Brewing Company on Orange Fridays. Join us from 5-7 p.m. Friday before the games designated on the opposite page. Life Members can enter to win a duffle bag each week. Iron Monk products are also available at the OSU Alumni Center and outside on the patio at all home games.
Alumni Association members may purchase game tickets at a 20% discount to three home games this season: South Dakota State, Arizona State (Homecoming) and Texas Tech!
Elevate your away game experience with us! Join us for events Friday nights and Saturdays at all Cowboy football away games.


A limited number of travel packages are also available to the BYU and TCU games that include hotel accommodations, welcome and pregame events, game day transfers and more.
Check in using the posted QR code at any game day event, and you’ll be entered to win a gift card from the University Store and shopokstate.com!





Chief Justice M. John Kane IV comes from a long line of public servants.
His great-grandmother, Mabelle Kennedy, was the assistant secretary of the treasury in the Truman Administration. His great-grandfather, M. John Kane I, was on Oklahoma’s first Supreme Court.
Kane’s father earned an agricultural economics degree at OSU before pursuing a legal career. Following suit, Kane earned a double degree in agricultural economics and accounting, aiming to have diverse career options with the ultimate goal of attending law school. This family history and the program’s reputation for preparing students for law school solidified his determination.
The knowledge gained from the added accounting education was invaluable in his practice.
“The business acumen that you get from studying accounting was of great assistance to me, not only in managing my practice of law but in understanding my clients’ needs,” Kane said.
From his parents’ era on campus, to his own in the 1980s, Kane watched the construction of new residence halls and the expansion of the athletics complex.
Kane also fondly recalled meeting his wife, Cindy, at the university.
“We didn’t have any coursework that would have had us bump into each other, but they had a ‘fix up your roommate with a blind date’ party, and her roommate decided that I’d be the perfect guy to go on a blind date with her,” Kane said. “And the rest was history.”
A particularly special aspect of Kane’s journey was the opportunity to practice law alongside his father and grandfather. He cherished the mentorship received and the invaluable wisdom shared by his semi-retired attorney grandfather.
“It was the greatest privilege of my life to do that,” Kane said. “You just have a special bond when your partner is also your parent. Now, of course, you may tend to expect more of each other because of that family connection sometimes, but it’s so worth it.”
Looking toward the future, Kane hopes his grandchildren continue the family legacy at OSU to become fourth-generation Cowboys, following in the footsteps of two of his four children, Matthew and Patrick.
“You’re going to get more than an education,” Kane said. “You’re going to get an opportunity to develop authentic friendships that carry you throughout your life.”







SPEARS BUSINESS MIS ALUMNUS’S JOURNEY FROM STILLWATER TO SPECIAL FORCES, CYBERSECURITY
Jerrad Ackerman is no stranger to stressful situations.
After all, he was a tactical communications specialist assigned to an assault squadron with the Naval Special Warfare Development Group, also known as DEVGRU or SEAL Team Six. But, walking into his own house one day in the spring of 2011 still ranks among his most nervewracking moments.
Less than a month earlier, he had returned home from a deployment that was supposed to be his last. Now, he was going to have to tell his wife, Allison, and their two young children that he was given another overseas assignment and would be headed back immediately. He couldn’t tell them what this last-minute mission entailed, where he was going or when he would return.
Allison knew Jerrad didn’t have a say in the matter, but she was still annoyed and disappointed. He was supposed to be done with these dangerous assignments. She knew not to ask a lot of questions because his job carried geopolitical ramifications, but she always wanted to know the danger level of the assignment on a scale of 1-10. If things went according to plan, he said, this had a high probability of being a 10.
“That’s not my favorite thing to hear,” Allison said.
Breaking the news to their 3-yearold daughter was just as tough. Allison held their toddler in a rocking chair as the couple tried to explain why Jerrad would be leaving again soon. In Allison’s frustration, she blurted out a line that the couple laughs about to this day.
“What, it’s not like you guys found Osama bin Laden,” Allison said in the most mocking tone she could muster.
Jerrad’s eyes got as big as saucers. A smile came over his face and he walked out of the room without saying a word.
The mastermind of the 9/11 terrorist attacks and the then most

wanted man on Earth had been on the run for a decade. Some, Allison included, thought bin Laden might never be found, but U.S. operatives in Pakistan had located a compound where he was thought to be hiding. SEAL Team Six had been given the assignment to raid the compound and capture the al-Qaeda leader.
Time was of the essence.
Weeks went by without hearing from Jerrad. On the morning of May 2, 2011, Allison woke up early with her daughter and flipped on the Weather Channel to check the day’s forecast. Instead of
the weather, the network had a special report. American forces had raided a compound near Abbottabad, Pakistan, and bin Laden was dead.
Allison dropped to the floor.
“I didn’t know if Jerrad had lived through it,” she said. “All I knew was that it was done, and from the Weather Channel, of all places. I just laid on the floor next to my daughter.”
It was 12 more hours before she knew for certain that Jerrad was alive. Hopefully, this would be the last assignment in a career that sounded like it came straight from the pages of a novel.
Jerrad Ackerman remembers the terrorist attacks of Sept. 11, 2001, like they were yesterday. Originally from Bartlesville, Oklahoma, he was a student at Oklahoma State University studying management information systems. He was glued to the TV in the Delta Tau Delta fraternity house dining room when United Airlines Flight 175 crashed into the World Trade Center’s South Tower. His father was also in Manhattan on business at the time, and Ackerman had no way to know if his dad was safe.
Watching the tragedy unfold, he knew he wanted to help in some way. How could he help protect America so this wouldn’t happen again?
“That was always one of those things that really resonated in my head through all the training courses or talking myself into jumping out of the back of a plane,” Ackerman said. “It’s what motivates you at the end of the day to go do stuff above and beyond. I saw it as more of a protection of the United States and this next generation. If we can push them back, then we can create a safety net for our kids.”
Ackerman earned his MIS degree from the Spears School of Business in 2002. After taking some cybersecurity courses at the University of Tulsa, he found himself in an excellent job as the vice president for information technology at Kero-Jet Corporation near Houston. Still, he felt a pull to serve his country in some way, and his first instinct was to become an FBI agent where he could put his background in information systems and IT to work.
However, a special agent at the Houston bureau told Ackerman he didn’t have enough life experience for the FBI. The best way to gain that experience was in the military, and the agent specifically urged Ackerman to pursue a special forces assignment.
Never one to back down from a challenge, Ackerman signed up for the Navy and headed for one of the most mentally and physically grueling programs on earth — Basic Underwater
Jerrad Ackerman with SEAL Team Six following a mission in Afghanistan in January 2011. The faces of the SEAL Team members are blacked out due to the classified nature of the mission.

“That [9/11 attack] was always one of those things that really resonated in my head through all the training courses or talking myself into jumping out of the back of a plane. ... If we can push them back, then we can create a safety net for our kids.”
– Jerrad Ackerman
Demolition/SEAL training, also known as BUD/S. The attrition rate for BUD/S is around 75%, and unfortunately, Ackerman joined that figure when he suffered a major knee injury that ended his dream of becoming a SEAL. It was yet another setback, and he faced months of knee rehabilitation at Coronado Island near San Diego.
Searching for his purpose in the Navy and in life, Ackerman met an officer named Joe Burns who changed Ackerman’s trajectory during a rehab run. The two had never met before, but the former sniper and Navy SEAL listened to Ackerman’s story and saw a higher calling. Burns thought Ackerman might be a great candidate for a new assignment working alongside the SEALs in a communications support role. The officer quickly became a mentor and made some phone calls that changed Ackerman’s life forever.
“You’re going to run into people throughout your career that really make the difference,” Ackerman said. “We all need mentors. We don’t get there on our own. We get there by talking to people,
engaging with people, letting people hear our story. And then they nudge you in the right direction. In my case, the direction was to a career path that I didn’t even know existed. If I can tell the next generation of students one thing, it’s that your life and career are a team effort.”
After a lengthy application and screening process, Ackerman reported to DEVGRU as a member of the special forces unit in 2007. While he wasn’t a Navy SEAL, he would be expected to keep up with his SEAL teammates in every way.
On top of doing his actual job, which consisted of establishing and maintaining tactical lines of communication with his teams and leadership during missions, he would be expected to suit up in the same body armor with over 100 pounds of gear, be able to fire the same rifle and navigate through the same swamps — only he had to be perfect or risk being sent home or reassigned.
“When you talk about a pressure cooker, this was it,” Ackerman said.
“They’re always looking at you when you’re out on the missions with them, every night whenever you’re deployed. It’s like, ‘That guy better keep up.’ So, you had to be in as good or better shape than every single one of your teammates. It was just a requirement.”
Ackerman learned how to keep up. He deployed to Afghanistan four times and once to Africa over four-and-ahalf years with DEVGRU. He was a part of approximately 120 direct-action missions, including the biggest one to date in the global war on terror — the raid on bin Laden’s compound.
During these missions, Ackerman would sometimes get a seemingly impossible assignment that took outside-the-box thinking to execute. For example, the squadron commander asked Ackerman to connect him with multiple battle locations, ships at sea and the White House, while also making sure that some members of the call couldn’t hear other parties due to sensitivity or security reasons.
Ackerman had extensive military network training, but these types of
tasks weren’t in the textbooks. They required a clever problem solver to find a way to get the job done because the lives of his teammates depended on it.
When he got these types of assignments, Ackerman couldn’t help but think back to his MIS classes at OSU and how they prepared him for this moment. He recalls a class on Java, the programming language developed in the mid 1990s, where Ackerman solved a question but went about it in an inefficient way. The professor didn’t dock him for the mistake, but instead armed him with the ability to see that there are multiple ways to solve every problem.
Another time, Dr. Rick Wilson gave an unorthodox quiz where he told students to read every word on the page prior to answering a single question. The last line of the quiz said to simply write your name and turn in the paper. Wilson deducted points for every problem the students attempted.
These moments in the MIS classes at OSU made a big impression on Ackerman, who understood that his professors were trying to show him a bigger picture.
“At the end of the day, the goal of our program is to create the next generation of problem solvers,” said Wilson, who is now the head of the OSU Department of Management Science and Information Systems. “Sometimes, in this field, we get bogged down in database applications, programming languages and all of these other tools, but that set of skills that you develop in solving problems is universal.
“When you’re faced with how to solve something in Afghanistan, it’s not about Tableau or Power BI. It’s about asking questions like, what do we control? What do we want to achieve? What constrains us? It’s about understanding that we have tools and how do we use them to solve the problem at hand? So, whether you’re a soldier, an HR director or the head of a winery, I want you to be able to think like a problem solver.”
Ackerman’s military career ended after that final deployment. He and Allison had a third child, a boy, and moved to Washington, D.C., where Ackerman was fortunate enough

to work for all three intelligence agencies — the National Security Agency, the Central Intelligence Agency and the Defense Intelligence Agency — as a contractor in aspects of covert communications, clandestine communications, cybersecurity and offensive cyber operations.
He spent two years at Anduril Industries, one year at Modern Intelligence, and currently serves as the principal director of cybersecurity and classified networks at Draper, a nonprofit engineering and innovation company that serves America’s interests and security needs.
Ackerman still gets to protect America and the world, just without the dangers of his previous profession. Most of what he does at Draper is labeled classified or highly classified, but his team consists of 110 people all working to solve America’s toughest cybersecurity problems.
“It’s been a really good run,” Ackerman said. “I’ve met Elon Musk at the White House. I got a coin from Ukrainian President Volodymyr Zelensky. It’s just been this massive roller coaster ride.”
That ride also included induction in February into the OSU MSIS Cloud of Honor, which recognizes graduates that have distinguished themselves in their professional careers, displayed transformational leadership or made exemplary contributions to their communities.
To say the least, Ackerman checks all of those boxes, but he deflects the credit. Instead, he sees the honor as a reflection of the mentors and loved ones that helped him reach this stage. Allison, on the other hand, couldn’t have been happier that her husband’s achievements were recognized by a school that means so much to him.
“That ceremony was really the first time he shared his story publicly,” Allison said. “And to be able to share the night with all of us, his family, it meant so much to him.
“For Jerrad, he had a plan for how he thought his life would go, and it really didn’t work out that way. God had other plans and was at work in his life, because if things had gone the way Jerrad wanted it to originally, he would never have done all these amazing things.”
On a Wednesday morning inside Stillwater’s downtown Aspen Coffee, you can find people of all vocations and backgrounds.
You wouldn’t expect a former intelligence officer to be sitting at a table, drinking an iced vanilla latte, but then again, hiding in plain sight for the Central Intelligence Agency was Meredith Woodruff’s job for 25 years.
That long career in the CIA would never have happened without Oklahoma State University.
America’s brightest shade of orange is in her blood.
Woodruff’s parents met while they were at OSU in the 1930s. Her mother, Cecelia, studied dietetics, and her father, Curtis Williams, studied history. Her father was quite involved at then Oklahoma A&M College, earning the rank of cadet colonel in the ROTC, being voted a student senator and president of his fraternity.
After marrying and graduating from OSU, her parents each earned graduate degrees, Curtis in law and Cecelia in dietetics.
But Stillwater soon called them home once again when Curtis began his law and political career as a county attorney. Cecelia became OSU’s lead
dietician, running the sole cafeteria on campus and feeding students three meals a day, seven days a week.
With the outbreak of World War II, Curtis’ unique skill set made him a vital asset to the United States. His strong language background, law degree and trustworthy Oklahoma values shaped him into an ideal candidate for the military’s judge advocate staff.
Woodruff was born in Washington, D.C., but her family joined her father in Germany shortly after WWII ended. The youngest of three, she was the only sister of two older brothers. She learned German as her first language and lived abroad until she was 5, when the family moved back to Washington, D.C.
However, when Woodruff was just 13, Curtis passed away. She and the rest of her family then moved back to Stillwater in 1961.
“Stillwater has always been the place that felt the most like home. Even after all the places I have been, it just feels right,” Woodruff said.
After graduating from Stillwater High School, Woodruff followed in her family’s footsteps and enrolled at OSU, where her brothers had recently graduated.
Woodruff was a brilliant student, graduating with two bachelor’s degrees in English literature and descriptive


“Stillwater has always been the place that felt the most like home. Even after all the places I have been, it just feels right.”
– Meredith Woodruff
linguistics. She focused on German and learned Hebrew. She was also a member of the Alpha Chi Omega sorority. As an honors senior, Woodruff had the opportunity to teach a freshman literature composition class, which she touts as one of her favorite memories at OSU.
“My time at OSU prepared me for all the writing I would go on to do in the CIA,” Woodruff said. “Oftentimes people would ask me ‘What Ivy League school did you go to?’ after reading my work, and they would be shocked when I told them I went to OSU.
“It just shows how great an education I received while studying here.”
After graduating from OSU, Woodruff wanted to attend law school like her father had.
She was accepted to Michigan and Harvard’s law schools but opted to defer from Michigan for a year to teach high school. During this time, she fell in

love with an old high school friend and Stillwater native, Freddie Woodruff. The two were married in 1972.
Shortly after their marriage, Freddie’s birthday was called in the draft lottery to serve in the Vietnam War.
“He already had a master’s degree, he had already lived in Canada for a while, and he believed he should go,” Woodruff said.
Freddie went through all the military testing required to fight in the war. Without speaking another language, Freddie scored a perfect score on the language aptitude test, leading the military to take an instant interest in his intelligence. They gave him the option of going to the Defense Language Institute to learn a new language, where he opted to learn Russian.
“Talk about decisions that impact your whole life,” Woodruff said.
Freddie graduated No. 1 in his class from the DLI, and he and Woodruff were sent to Germany to continue his work for the Army Security Agency. While
they lived in the country where she was born, Woodruff earned a master’s degree in psychology from Wayne State University’s international program in Berlin.
Because of his Army work, the CIA soon recruited Freddie to join the Clandestine Services division, the agency’s most secret and confidential branch.
By then, Woodruff and Freddie had welcomed their first daughter into the world. For Woodruff and their first child to travel overseas with Freddie on his tours, she would have to undergo the same training Freddie was taking, and she would have to do it all while pregnant with her and Freddie’s second child.
“It was such fun; it was a lot of hard work. I did well at it. They had never had a wife who had been able to do it all successfully,” Woodruff said.
Woodruff finished the training and moved to Russia with Freddie to begin his first tour in 1979. The family returned stateside with two children
in tow in 1981, where the head of the CIA’s Soviet Division was there to congratulate Freddie on a job well done … or so they thought.
“Turns out, he was really there to ask what I’d think about coming into the agency,” Woodruff said.
A CIA push to hire more women within the government was sweeping across the country.
Woodruff became the first married woman hired by the agency as an operations officer, as well as the first to have children already. Thanks in part to her training history, working alongside Freddie and having done a tour overseas, she finished top of her class and was ready to embark on her first mission.
The Woodruffs went on a combined four overseas tours during their service in the CIA before Freddie was killed on a mission in 1993.
After Freddie died, Woodruff continued her work in the CIA in many different roles and would go on three more overseas tours.
Woodruff became a vital asset to the U.S. government, working in Clandestine Services for more than 25 years in Central Eurasia, the Near East, Africa and Europe. Many of these operations are still classified and Woodruff can’t discuss them publicly.
In 1997, while serving in Europe, Woodruff received a phone call from Deputy Director of CIA for Operations Jack Downing, recalling her home to Washington to put together a recruitment center to bring in an unprecedented number of new officers.
Woodruff also began formulating a plan to recruit women specifically to apply for operational positions within the CIA.
“I said, ‘I want to be on television. I want to be on radio. I want to do magazine ads and be pretty open about this.’ My boss said, ‘You’re nuts.’ I said, ‘Do you want the numbers, or do you not want the numbers?’ He said, ‘OK,’” Woodruff said.
Woodruff took out an ad in The Economist titled “Do you have what it takes?” to reach potential applicants. The ad ran on Sunday, and by Thursday, they had thousands of applicants.
Woodruff served as a chief of station, division chief and center chief before retiring in 2008 as the agency’s most senior female operations officer after over 25 years. She holds the CIA’s most prestigious awards: the Donovan Award for Operational Excellence and the Distinguished Career Intelligence Medal.
After retirement, Stillwater called Woodruff home yet again. She purchased 15 acres of land to build what she calls “a cowboy house.”

It didn’t take her long to get involved in the community she had always held so close to her heart. For years, Woodruff was a part of the OSU Friends of Music organization with the Michael and Anne Greenwood School of Music.
In 2023, she was initiated into OSU’s chapter of Phi Beta Kappa Honor Society, the country’s oldest and most esteemed honor society. In October, she will be honored as a College of Arts and Sciences distinguished alumna.
Along with these honors, Woodruff is also an OSU Osher Lifelong Learning Institute instructor for the Stillwater and Tulsa campuses. She has taught international history and aspects of U.S. intelligence classes to aid in OLLI’s mission to help seniors stay active and social.
She has become a popular public speaker, addressing topics such as international events, the U.S. intelligence community and the life of a real-life spy.
She recently partnered with two former colleagues, John Sipher
and Jerry O’Shea, in Spycraft Entertainment, a global production company focusing on more realistically representing U.S. intelligence.
Woodruff will tell you, though, that being a member of the OSU Global’s Ambassadors Board is currently her greatest passion.
“What I love about OSU Global is their emphasis on the practical rather than theory,” Woodruff said. “Everything has action and a purpose with real-world application.”
Woodruff works closely with OSU Global Dean Randy Kluver. When Dr. Kluver arrived in 2017, they sat down to discuss the idea of the school offering certificates so that students would have an opportunity to further their education in more specific areas in a global landscape.
“Meredith has been an invaluable resource and ally for OSU Global and the School of Global Studies,” Kluver said. “Her amazing experience, her global perspective and her strategic understanding have helped us to guide our academic programs, to position the university globally, and to develop a clear strategy for the future to help make OSU a truly global university with an international impact.”
Along with advocating for more opportunities for OSU Global students, Woodruff occasionally speaks to Dr. Jami Fullerton’s public diplomacy classes.
Woodruff also works closely with the OSU Foundation, providing the “Meredith Woodruff and Donald Garner Endowed Scholarship” for OSU Global students.
Nowadays, you can find Woodruff around Stillwater attending various social functions of her respective clubs and organizations. She is always looking forward to what is next in her busy schedule but enjoys spending time with her husband, Donald Garner, a 1959 OSU engineering alumnus who played football and basketball for Cliff Speegle and Henry Iba.
“It’s good to be home. Stillwater is such a great place to live, but OSU is what makes it exceptional,” she said.


Experience all that our world has to offer in the company of fellow alumni and friends with the OSU Alumni Association’s Traveling Cowboys program.
Enjoy a worry-free experience as our staff and travel partners take care of all the arrangements so you can explore and relax. While visiting exotic, historical or educational destinations, you will have the added value of traveling with other Cowboys and reconnecting to your alma mater in an exciting way!
Scan the QR code to visit ORANGECONNECTION.org/travel and learn more about our upcoming 2025 trips.

TAHITI & FRENCH POLYNESIA FEB. 21-MARCH 3
CLASSIC SAFARI: KENYA & TANZANIA JAN. 23-FEB. 7
WONDERS OF PERU FEB. 8-19
KIWI AND KANGAROO COASTS OF AUSTRALIA AND NEW ZEALAND FEB. 24-MARCH 10
HAWAII THREE ISLAND ADVENTURE MARCH 11-19

Experience Tahiti as you cruise the islands of French Polynesia. Tahiti and its celebrated neighbors— Mo’orea, Ra’iatea, Taha’a, Bora Bora and Huahine— distill the essence and allure of the South Pacific. Explore spectacular history, rich culture and unique topography on a luxury itinerary that includes a seven-night cruise aboard the small ship Star Breeze.
JOURNEY THROUGH BRITAIN JULY 21-AUG. 3
NATIONAL PARKS AND LODGES OF THE OLD WEST JUNE 20-28
NORWEGIAN FJORDS AND THE MIDNIGHT SUN JUNE 22-JULY 2
SCANDINAVIA AND THE BALTIC SEA JULY 20-30
ALPINE SPLENDOR: SWITZERLAND AND AUSTRIA JULY 24-AUG. 6
ICELANDIC REACHES JULY 31-AUG. 11
FRONTIER ADVENTURES AUG. 8-18
BUCOLIC BRITISH ISLES AUG. 24-SEPT. 3
DISCOVER THE CANADIAN ROCKIES BY RAIL AUG. 27-SEPT. 2
CHARISMATIC CANADA AND NEW ENGLAND SEPT. 13-24

On this 14-day small group tour, see history come to life and enjoy Great Britain’s timeless hospitality. The journey begins in Edinburgh then spend two nights on Lake Windermere’s shores, enjoying an idyllic cruise. Explorations in Wales include Bodnant Garden, Conwy Castle, and a scenic train ride through Snowdonia National Park. Returning to England, visit Shakespeare’s Birthplace in Stratford-uponAvon and spend two nights in Bath. After stops at Stonehenge and Windsor Castle, encounter London’s celebrated landmarks during a two-night stay.

Surround yourself in Japanese customs and traditions on a 12-night cruise. Enjoy Nagasaki’s volcanoes and offshore islands and see the art scene and beautiful beaches of Busan. Stroll through the landscaped Hiroshima Gardens or visit Hiroshima Castle then spend a few days in Kyoto. End your trip with the views of Mount Fuji from the seaport in Shimizu.
REVELATIONS OF JAPAN APRIL 13-24
PANAMA POTPOURRI MARCH 23-APRIL 2
DUTCH WATERWAYS
APRIL 8-16
THE 89TH MASTERS
APRIL 11-14
THE GALAPAGOS ISLANDS (NORTH) MAY 10-17
CULTURAL CAPITALS OF SPAIN MAY 20-29
NORTHERN ITALY JUNE 7-21
ICONIC MEDITERRANEAN JUNE 7-21
GREAT EUROPEAN JOURNEY JUNE 7-21

Join a seven-night Seine River cruise that showcases colorful Norman cities and the majestic City of Light. Sail round trip from Paris and stroll through centuries-old towns, including Rouen and maritime Honfleur. Delve into the history of the D-Day invasion at Normandy’s beaches and the Caen Memorial Museum. Walk through gardens at Claude Monet’s home, gaze in awe at Versailles. Experience the charismatic districts and landmarks of Paris, from the Notre-Dame Cathedral to the Latin Quarter.
GRAND SEINE RIVER AND NORMANDY PASSAGE OCT. 16-24
HELLENIC INSPIRATION SEPT. 26-OCT. 3
BALLOON FIESTA OCT. 3-6
MEDITERRANEAN MELANGE OCT. 29-NOV. 8
HOLIDAY MARKETS CRUISE DEC. 12-20
Be sure to scan the QR code to visit ORANGECONNECTION.org/travel and learn more about all of our 2025 trips.



OSU’s Tactical Fitness and Nutrition Lab provides vital wellness resources for nation’s first responders




Firefighters, law enforcement officials, military personnel and emergency medical workers are the first responders in emergencies, risking their lives daily to save others and provide critical aid.
These tactical athletes are thrust into life-threatening situations at a moment’s notice to ensure people’s security and safety, which can put them at risk of unique health problems and even premature death.
Often, first responders’ health and fitness are overlooked, and the resources to make changes are limited.
In 2019, Oklahoma State University took a step to optimize health, fitness and performance for these populations by establishing the Tactical Fitness and Nutrition Lab.
Co-directors Dr. Jay Dawes, professor of applied exercise science, and Dr. Jill Joyce, associate professor of nutritional sciences, created the lab to help tactical athletes perform their jobs safely and efficiently during their careers and retire healthy.
Together, Joyce and Dawes are exploring opportunities to work with OSU’s Human Performance and Nutrition Research Institution to accelerate the land-grant mission and fuel the work they are already doing with tactical athletes.
“There’s this awesome culture on campus when it comes to research. People often get very competitive, and it’s cutthroat. That is not the culture here,” Joyce said. “We are very supportive, and I think HPNRI fits in beautifully with that. I expect them to continue helping make connections.”
The lab collaborates with an organization to evaluate their fitness and nutrition. OSU then provides strategies to guide personnel toward a healthier path.
Forty-five percent of firefighter on-the-job deaths are from heart attacks, not fire, Joyce said.
As firefighters rush to the scene, their hearts race and blood pressure spikes. The combined stress of the urgent task, along with personal factors such as fitness level, hydration and nutritional status can increase strain on their heart.
Despite these demands, a healthy firefighter’s body can handle the
“There’s this awesome culture on campus when it comes to research. People often get very competitive, and it’s cutthroat. That is not the culture here. We are very supportive, and I think HPNRI fits in beautifully with that. I expect them to continue helping make connections.”
DR. JILL JOYCE , ASSOCIATE PROFESSOR OF NUTRITIONAL SCIENCES






pressure, minimizing the risk of major health issues or death.
“Research on big groups of national firefighter deaths found that none occurred in healthy individuals,” Joyce said. “They all occurred in people who had underlying heart disease, high blood pressure, which could be because of the job, but also factors like high cholesterol, obesity. Nutrition, followed by physical activity are the leading risk factors for those. I would say the job pulls the trigger, but lifestyle loads the gun.”
Joyce collaborates with first responders and their families on nutrition. Common practices for the general public often don’t work for tactical athletes, making it challenging to meet their nutritional needs.
“If somebody eats out too much, and they’re not eating healthy food when they eat out, my students always suggest they should pack their lunches, but when you work in a car for 10 hours a day with no fridge, freezer or microwave — it’s a curveball,” Joyce said.
Brittany Wheeler, Colorado State Patrol wellness and fitness coordinator, learned that officers want more nutrition material, which prompted her to connect with Joyce.
“This whole concept of making wellness more important in our agency is probably like six, seven years old now, but it takes forever to change culture,” Wheeler said. “She helped me dial down the material to the specifics, like learning how to read a nutrition label.”
As an instructor at the academy, Wheeler has 23 weeks to work with cadets teaching them the basics of nutrition and wellness.
Outside the academy, Wheeler provides officers with resources such as Joyce’s nutrition classes and a handout showing how to eat healthily at a restaurant.
“That was huge just to start that conversation,” Wheeler said. “We can’t always bring our food. We’ll have 14-hour shifts, where you have to go to a gas station, or you’ll have to stop for fast food, but to create that awareness piece is great.”
It’s challenging to find tactical athlete specific resources in a world where new
“You have to meet people where they are. They have to start changing, changing the culture, and creating those conversations and just start super simple.”
BRITTANY WHEELER,
COORDINATOR
health trends emerge every day. Wheeler said having access to Joyce and Dawes is important to ensure the information she shares is accurate.
“It’s just one of those things that you’ve got to start somewhere,” Wheeler said. “... You have to meet people where they are. They have to start changing, changing the culture, and creating those conversations and just start super simple.”
Typically, unhealthy snacks or baked goods are found on fire station countertops that firefighters picked up at the store or were delivered by the community, Joyce said. Often those foods are leading to health issues.
“Usually, the food environment is set up to destroy them,” Joyce said. “That’s not going to fuel performance or health. We are looking at department-level changes. Should we have a policy that says no junk food on the counters? Should I put out a PSA that says bring fruit baskets and veggie trays? We’re trying to set up systems so that they have knowledge and skills, but also the environments, the cultures, the people that allow them to do that.”
As part of dietary assessments, Joyce provides nutrition report cards with color codes and letter grades to highlight areas of concern and how to improve. Then,
they teach them how to set up their home food environment to support instead of sabotage them and how to eat healthy while dining out.
“I can teach firefighters all day long how to eat healthy, and that gives them knowledge and maybe even skill, but if the environment isn’t set up to let them use that knowledge and skill, then they can’t use it,” Joyce said. “I need to figure out what’s going on beyond them, to get them to be able to do that.
“We create interventions that departments can put their people through, that will address knowledge and skill and readiness of the group, so they’re all more supportive and ready to do this, and then we’ll work with departments to alter the food environment.”
Kim Wiesmann, public health specialist for the Indianapolis Fire Department, evaluates firefighters’ health and safety issues and identifies interventions to mitigate or prevent them.
“We’re always trying to reduce our overweight and obese firefighters,” Wiesmann said. “We’re trying to reduce cholesterol, blood pressure and metabolic syndrome, and so one of the big areas that
we feel that we can do that is through nutrition.”
The resources Dawes and Joyce supply aren’t one size fits all. In fact, they give detailed assistance in specific areas.
“I can take a look at our data, see where we’re having issues, and then utilize Jay or Jill as a resource to help us, then focus on what we really need to do that could maybe help with that issue,” Wiesmann said.
Currently, in the IFD recruit school, recruits are taught how to cook healthy meals in the station and meal prep dishes to better prepare them to be healthy on the job.
As a government agency, resources can be limited when trying to implement evidence-based practices and it can be hard to find individuals who are willing to help.
“I’m just so grateful for Jill and Jay because they are so willing to offer up advice and resources when I can’t always give them something back,” Wiesmann said.
Tactical athlete requirements are like professional athletes as far as strength and power, speed and agility, except they perform on a moment’s notice with occupational loads and wear personal protective equipment — which, combined

with shift work and unhealthy lifestyles, puts stress on the body.
On the physical fitness side, Dawes conducts research on topics ranging from public health to high-level performance to help first responders efficiently perform throughout their careers.
“We look at what fitness standards will help best predict job suitability, health status and fitness status,” Dawes said. “We also look at different types of practices within the profession to see if they are the most efficient ways of going about performing certain job tasks.”
Exemplifying OSU’s land-grant mission, the lab is a mobile unit where the testing and assessment equipment is easily transported into a community to meet the needs of tactical athletes to help combat the challenges they face in their jobs and everyday lives.
“We’ve done physical assessments, provided some sample training programs and individualized wellness programs. We work with their lead wellness team member to implement different strategies to help them continue to be more fit, and we really introduce that health and wellness lifestyle within the organization to help transition the culture to one that’s more health and wellness oriented,” Dawes said.

Along with the Warriors Rest Foundation, the lab is working with the Edmond Police Department to set up an in-house wellness program.
“In a lot of cases, what we have to do is undo what the job does to them,” Dawes said. “At the end of the day, they’re not playing for trophies and medals. It’s about life and death, public safety and national security. At the end of the day, they’re trying to preserve safety and lives.”
Following a nationwide push for holistic wellness programs in law enforcement, the EPD started a wellness program.
Stephanie Williams recently became the full-time wellness coordinator, but her work with EPD began in a smaller capacity in 2022 as she provided counseling services following the department’s first line of duty death.
Through that experience, Williams sparked conversations surrounding mental health and self-care and learned the officers were interested in their health.
“One of the things people were really interested in is physical fitness and nutrition, because it is different for law enforcement officers than it is for me or the general public, because of their shift
work and the high cortisol levels,” Williams said.
Through the partnership with the lab, Dawes performs assessments and then creates strategic workouts for the officers that Williams can post around the gym for optimal performance.
“The difference between his type of workouts and what other people do is he’s able to put in both strength and flexibility exercises, because if you get called out in the middle of your workout, you’ve got to go. He wants to make sure there’s not going to be any injuries,” Williams said.
Williams said many times officers don’t know where to start because their body is in a different condition than when they left the academy. So, EPD hosts social functions to encourage officers and their families to start their physical fitness journey which also helps strengthen their mental health.
“What we know about wellness is that wellness works within police departments, wellness works when we include the family,” Williams said.
Williams has worked with first responders for 20 years and has seen how those that lack fitness or nutrition struggle with sleep, clear thinking and mental health issues. People in these careers also tend to retire earlier than

those in other career fields, but they typically live just five to seven years after retirement.
And while EPD is still new to the lab, Williams is already seeing changes in how officers reach out to Dawes about tiny injuries instead of pushing through the pain. Her goal is for everything to come together to help people feel better physically and mentally on the job and in retirement.
“What this partnership is offering is so amazing,” Williams said. “It has a ripple effect, not just within our law enforcement officers or our first responders and their families, but also, that ripple effect goes to the community. These officers are dealing with people on their hardest days, and so when they’re taken care of, their family life is better, but I think our communities are better too.”

Scan


OSU’s Wakeboard Club exceeded its goal of 100 donors. After winning ambassador prizes, the Hourly Donor Challenge 13 times and Philanthropete Challenges, the club purchased a new boat, which it plans to debut in the fall.
Campaign’s success underscores dedication and loyalty of the Cowboy family
Once again, Oklahoma State University's annual day of giving exceeded expectations, raising an impressive $1,373,282 from 2,416 donors. Held April 2-3, Give Orange 2024 saw remarkable participation from the Cowboy family, showcasing their support for OSU.
An important component of this year's success was the collective generosity of the OSU Foundation Board of Governors, a group of alumni and friends dedicated to supporting the university. Their giving generated $424,600 from 1,867 donors, benefiting 306 OSU funds.
Give Orange ambassadors — passionate members of the OSU community who play a crucial role in inspiring donations — elevated the campaign’s message. Ambassadors who received the most donations earned additional funds for their orange passion. Their fundraising efforts resulted in 414 gifts totaling $27,966.
Give Orange's leaderboards, challenges and matching gifts provided additional incentives for participation,
fostering a spirit of friendly competition. OSU alumni chapters, such as the newly established Kingfisher County Alumni Chapter — comprised of about 50 members — capitalized on the Small Alumni Chapter Leaderboard and other opportunities, raising $4,926 for scholarships.
Micah Daugherty, president of the Kingfisher County alumni chapter, emphasized the excitement the challenges and leaderboards generated.
“The competition made it really fun, and I feel like we had a great core group that helped us be successful,” she said. “We shared the giving link to get as many gifts as possible.”
OSU Wakeboard Club President Jeremy Halbach was the top performing Give Orange ambassador and won the Hourly Donor Challenge 13 times, earning $250 each time. Halbach's efforts, along with the club's winnings from challenges, propelled the club beyond its goal of 100 donors and raised the needed funds to buy a new boat.
“I met with the club’s executive team, which consists of about eight
“Give Orange is transformational thanks to every one of our donors.”
REBECCCA NIEVAR, DIRECTOR OF ANNUAL GIVING AT THE OSU FOUNDATION
different people with specific titles. I gave everyone a specific task,” Habach said. “Fortunately, we have outstanding club members who wanted the new boat, so they followed the executive team’s plan to make the purchase happen.”
Reflecting on the overwhelming support received, Rebecca Nievar, director of annual giving at the OSU Foundation, expressed gratitude for donors’ generosity.
"The OSU family shows up for each other,” Nievar said. “One matched gift can fund an organization, expand scholarships or support students in need. Give Orange is transformational thanks to every one of our donors.”
• $1,373,282 from 2,416
• The OSUF Board of Governors’ collective giving more than doubled last year’s with $141,100 to the general challenge fund. The general funds generated $424,600 from 1,867 donors, benefiting 306 OSU funds.
• 2024 Give Orange ambassadors inspired 414 gifts totaling $27,966


After making a gift during Give Orange, students gathered at the OSU Student Foundation table to assemble friendship bracelets. The first 150 OSU students who donated to Give Orange unlocked $5,000 to the


Thanks to the generosity of Mark and Karen Mitchell, the first 75 donors to OSU Counseling Services unlocked an additional $75,000 to support mental health services for OSU students.

The new Kingfisher County Alumni Chapter, comprised of approximately 50 members, donated $1,493. After the leaderboard winnings and ambassador prizes, they raised $4,926 for scholarships.

In celebration of its centennial, the first 100 donors to the Cleo L. Craig Child Development Lab unlocked $75,000 in scholarship support for future early childhood educators and OSU students at the CDL.
OKLAHOMA AEROSPACE INSTITUTE FOR RESEARCH AND EDUCATION CONDUCTS GROUNDBREAKING RESEARCH IN NUMEROUS WEATHER-RELATED AREAS


“Nature is so powerful, so strong. Capturing its essence is not easy — your work becomes a dance with light and the weather.”
— Annie Leibovitz , photographer
Weather’s unpredictability can change seasons in an instant and turn a bright, sunny day into a tumultuous, confounding chaos with little to no warning.
A team at the Oklahoma Aerospace Institute for Research and Education hopes its research in numerous areas dedicated to observing, predicting and assessing weather-related phenomena might influence the future of meteorology.
From research to Extension, from weather damage


assessment to gravity wave generation, OAIRE continues to fulfill its land-grant mission from the skies.
The sound of a runaway locomotive barreling out of control toward you.
That’s how some have described the aura of a tornado, and the aftermath can
A recent partnership with faculty in the School of Civil and Environmental Engineering and the National Weather Service office in Tulsa has allowed engineers from OAIRE to lend aerial assistance in identifying and assessing a tornado’s path of destruction.
“Like the sound of a tree falling in the woods, a tornado doesn’t truly exist unless it is seen by an eyewitness or there is sufficient damage to suggest that
a tornado touched down,” said Dr. Jamey Jacob, OAIRE executive director and professor and John Hendrix chair in the School of Mechanical and Aerospace Engineering. “For that reason, the damage assessments conducted by individuals from emergency management teams and National Weather Service personnel after the fact are crucial to understanding the characteristics of a probable tornado.”
Once a tornado occurs and there is confirmed damage — in the two Oklahoma towns of Barnsdall and

Claremore for instance — a team of pilots and engineers from OAIRE deploy to the site to provide aerial coverage.
The team uses a vertical take off and landing fixed-wing uncrewed aircraft system, or UAS, to rapidly assess an area to determine the direction and length of the damage path, which it uses to plot a course for a fixed-wing aircraft called a Wingtra. The Wingtra is generally used for agricultural or surveying purposes, which is a simplified explanation of what the OAIRE team is conducting during flights. The UAS allows the team to cover more area rapidly and boasts an extended flight time compared to other aerial systems.

The UAS will autonomously traverse its preprogrammed flight path in a “lawnmower type path” at an altitude of nearly 400 feet while taking highly detailed photographs of the area at predetermined intervals.
“The flight process is fairly simple,” said Emalee Hough, an R&D engineer at OAIRE. “Once we program the flight path, we become observers that watch out for possible points of interference such as other aircraft. The ‘harder’ part is when the flight is done and we sometimes have thousands of photos to process.”
After the assessment is completed, each photo is geotagged with info and uploaded into a 3D rendering software, which stitches together each photo pixel to provide as accurate a 3D model as possible.
These renderings are then disseminated to other researchers and weather personnel to provide a more accurate and detailed assessment of the damage, path, longevity and other characteristics of a supposed tornado.
The CIVE faculty researchers hope that examining the destruction caused by a tornado, specifically to structures, may provide insight into how to construct
more robust buildings and infrastructure able to better withstand a tornado’s destructive forces.
“Assessment of the damage to civil structures after natural hazard events such as tornadoes is critical for emergency response operations and mitigation of the risks of future events,” said Dr. Maha Kenawy, assistant professor with CIVE. “Rapidly evolving unmanned aerial technologies and emerging data-driven approaches have created unique opportunities for advancing post-disaster damage assessment of civil structures.
“Our research team will integrate physics-based and data-driven modeling techniques to improve and accelerate the processing and interpretation of civil infrastructure damage data collected by unmanned aircraft systems. This work will also help identify infrastructure vulnerabilities that can be addressed to increase the resilience of communities across the U.S. against intense tornado events.”
For weather researchers, these aerial assessments provide a faster, more precise representation of the destructive path of a tornado, which may help to
"Like the sound of a tree falling in the woods, a tornado doesn't truly exist unless it is seen by an eyewitness or there is sufficient damage to suggest that a tornado touched down."
Dr. Jamey Jacob , OAIRE executive director
better understand the characteristics and behaviors of these seemingly unpredictable storms.
“This really is an extension of our land-grant mission,” Jacob said. “To help our communities assess and better understand these weather phenomena will hopefully lead to developments that can mitigate the impact they have on our citizens. In the not-too-distant future, I foresee emergency management teams, utility companies and weather researchers alike implementing assessment systems like these to further enhance response times and impact research.”
Until that vision becomes a reality, the OAIRE team is ready to lend its expertise to help individuals and communities affected by these powerful storms.
“It’s a humbling and amazing experience to be a part of this project,” said Allan Burba, an OAIRE flight crew member. “It’s hard to grasp the destructive forces of these storms and the devastation they can cause until you see it up close and personal. Being a part of research that may someday lessen the impact a tornado can cause is amazing.”
As a native Oklahoman, Hough has a unique connection to severe weather and the unpredictability of tornadoes.
“I grew up watching these storms and being terrified of them,” Hough said. “Barnsdall was the first tornado damage I’ve seen up close, and to be able to help my neighbors and their communities and progress the science and research into these storms is really important to me.”
The recent solar eclipse provided an amazing viewing experience for astronomy enthusiasts and hobbyists alike. For OAIRE engineers, it was an opportunity to conduct unique research “in the shade.”
Sixteen OSU students and faculty members were joined by NASA representatives at the Choctaw Nation Community Center in Broken Bow, Oklahoma, where they conducted research as part of the NASA National Eclipse Balloon Program.

The team launched balloons to gather atmospheric data for nearly 36 hours surrounding the eclipse.
Jacob likened the eclipse’s effect to that of a pebble in a pond.
“Just like a pebble causes waves in the water, the eclipse causes gravity waves in its wake as it moves across the Earth, and we wanted to measure those disturbances,” he said. “These waves are essential for transporting energy in the atmosphere. They’re good at mixing the air and act as conveyor belts to help move energy and moisture from one location to another just like waves in the ocean.”
Jacob said the goal was to take the atmospheric readings from such a rare but known event and use it to provide general improvements to numerical weather prediction models.
“The atmosphere is so complicated to model — it’s just a very complex phenomena,” he said. “The eclipse provided a way to verify existing models using a known condition.”
OSU was one of 50 teams across the U.S. to participate in the NASA program, with OSU serving as an atmospheric science pod lead.
“We were responsible for organizing and supporting other teams leading up to the eclipse and bringing their data together post-event. We had teams
spread out between Texas, Oklahoma and Arkansas,” Jacob said.
The OAIRE team also had a distinction from others compiling data; Dr. Brian Elbing, renowned OSU tornado researcher, incorporated infrasonic arrays into the data collection arsenal to better understand how those systems work for tornado detection.
“The solar eclipse can generate gravity waves within the atmosphere and these induce pressure fluctuations within the atmosphere,” Elbing said. “The pressure changes occur over long periods of time and can be detected as very low frequency sound known as infrasound.”
As a Choctaw citizen and planetary scientist, this event has special meaning to OSU Aviation and Space assistant professor Dr. Kat Gardner-Vandy, who used the event to help achieve goals for her NASA Science Activation project, Native Earth | Native Sky (NENS).
“Seeing the eclipse from Choctaw Nation was truly remarkable,” Gardner-Vandy said. “Through NENS, we co-created curriculum with the Choctaw Nation about the story of Tvskha and Walo, two young boys who left their home on foot to find where the Sun died each night. They eventually
made it to the Sun and talked to him and his wife, the Moon. Including this story in our science curriculum and then experiencing the solar eclipse with other Choctaw citizens demonstrates the beautiful interweaving of Native stories and science. Talking about our curriculum, passing out eclipse glasses and seeing Choctaw youth help launch balloons with OAIRE were huge highlights of the day.”
OAIRE also took drones to serve as a repeatable system taking the same measurements. Jacob said someday the balloons that carry the instruments will be replaced by drone fleets.
Zach Yap, a research and development engineer with OAIRE, has been conducting research with OSU for years, including as an undergraduate and graduate student.
“This was a wonderful opportunity to see what happens when you essentially turn off the sun and have a rapid onset of darkness,” he said. “An eclipse is an interesting and unique way of

generating atmospheric gravity waves. They happen between different layers in the atmosphere, and the waves are good movers of energy for storms and other things. If we can better understand how these waves propagate through the atmosphere, we can better — on a continental scale — forecast weather systems.”
In addition to OSU leading several other universities, OAIRE researchers had the opportunity to be a resource for students at Gordon Cooper Technology Center in Shawnee, Oklahoma, and high schools in Okmulgee, Oklahoma.
“Through the NEPB and OSU, we can give them the opportunity and resources to learn from these opportunities,” Yap said. “By doing this, we can share this knowledge and inspire them to pursue a STEM career.”
Freshman Research Scholar Lily Yates from Sapulpa, Oklahoma, was part of the OAIRE research team assisting with balloon launches. Conducting weather research is her career and life goal.
“My experience with research at OSU has been absolutely amazing,” she said.
Jacob said the effort included the whole range of student involvement.
“On the science side, we had high school, undergraduate and graduate students working together, and while at the eclipse, we used the opportunity for science outreach for younger kids and to our tribal partners,” he said. “The eclipse itself is a cosmic marvel that inspires awe in all who see it. What better way to reach the next generation of scientists and engineers?”

Scan to learn more about OAIRE.


Twice every day, Taylor Williams is in the barn working with horses on his family’s 33-acre horse ranch. He lives the life of a true cowboy, one he learned from his family.
His grandfather, Fred “the Lawman” Williams, was the first Black cowboy to start the Pony Express, a horseback baton relay race in Oklahoma. Riders race around the arena holding the baton until the first team to drop it in a barrel wins.
In addition to racing at the Pony Express, Williams handles all care and maintenance for his horses. Since he was a boy, his mother, Tiffini Williams, said he dreamed of becoming a veterinarian. Williams started his educational career at Oklahoma State University in the fall of 2019 to pursue his dreams, majoring in animal science.
“Taylor chose OSU because it was close to home while also being one of the best vet schools in the nation,” said Reggie Williams, Taylor’s father. “When we take our animals to the vet and I look at the wall, they almost always graduated from OSU.”
Before graduating in May 2023, Williams was a member, treasurer and president of Alpha Phi Alpha Inc. He was on the scout team for Cowgirl basketball, in NAACP, Afro-M, Black Student Association and the Retention Initiative for Student Excellence (RISE) program during his freshman year.
“When he was a senior at OSU, he was so involved on campus and maintained a 3.8 GPA while taking the difficult classes required for vet school,” Tiffini said. “Taylor would always tell me he had to take care of what was important to him, and his grades came first.”
As a hobby, Williams began taking pictures in the outfits he wore and
posting them on social media. He was modeling locally for brands in Oklahoma City and friends with clothing lines when an agency discovered his Instagram and recruited him to walk as a model for Louis Vuitton at Men’s Fashion Week in Paris.
“They emailed me, and I didn’t think it was real at first,” Williams said. “I looked into it, and they actually wanted me to come to Paris to model in a new cowboy clothing line.”
Grammy Award-winning artist Pharrell Williams — in collaboration with Louis Vuitton — paid tribute to the American West wardrobe in the show by including cowboy shirts, chaps and workwear with details like turquoise beading.
“Pharrell wanted me because I’m a real cowboy,” Williams said. “When I met him, he was so excited I wanted to model for them. He repeatedly thanked me for taking time to come to Paris to model with him.”
Following fashion week, Williams’ primary focus has shifted back to his educational career. This August, he will begin his pursuit of a doctorate at OSU’s College of Veterinary Medicine.
Williams will continue his dreams and pursue a career as a large animal veterinarian, and he hopes to open his own clinic in his home state. He hopes to continue modeling and rodeoing as side hobbies but will ultimately prioritize his dream to be a veterinarian.
“Taylor is used to having a full plate,” Tiffini said. “He excels at everything he does. Modeling on the side, as well as being a veterinarian, might be tough, but we know he’s going to succeed, even if it means little sleep. That’s what he’ll do.”

OSU Museum of Art celebrates 10 years of campus and community enrichment

When the Oklahoma State University Museum of Art opened its doors to the public in 2014, it had a newly renovated building, a growing collection, a handful of staff and a lot of promise.
“Art is often made out to be exclusive, but we wanted to change that,” said OSUMA interim director Carla Shelton, who was hired in 2012 to plan and oversee the museum’s permanent collection. “Over the past 10 years, we’ve hosted amazing artists and
“Over the past 10 years, we’ve hosted amazing artists and shows that are accessible to audiences of all levels. It’s about exposure and bringing people together so they can have a conversation.”
Carla Shelton
OSUMA Interim Director
shows that are accessible to audiences of all levels. It’s about exposure and bringing people together so they can have a conversation.”
The concept for the museum began in earnest after former OSU president Burns Hargis and his wife, Ann, secured the help of two key alumni: Universal Limited Art Editions owner Bill Goldston and philanthropist Malinda Berry Fischer. Through their art world connections and expertise, the museum started to take shape with an advisory council and donated artworks.
“The motivation was to enhance the reputation of OSU as a comprehensive research university and to educate our students in art appreciation and encourage their creativity,” then president Hargis said. “As a land-grant university, one of OSU’s missions is to share the expertise and discoveries on campus. An art museum would serve the citizens of Stillwater and the state, as well as the OSU community.”
A significant step in establishing the museum came in 2010 with OSU’s acquisition of the Postal Plaza Building in downtown Stillwater. Built in 1933 as a federal post office, the building had been used as business and church office spaces since the late ’70s.
“I will not easily forget the hours spent working with campus facilities to manage the climate systems and the challenges inherent in having a
basement in Oklahoma,” said Vicky Berry, the museum’s first director, who retired this spring. “Revitalizing an old post office provided many challenges ... and yet we were able to marry the building’s character with its new purpose.”
Once renovations were completed in 2013 — OSU grad and architect Rand Elliot designed and supervised the project — the museum team moved hundreds of artworks into the climate-controlled vault. The OSUMA permanent collection has since grown to more than 5,000 gifted pieces.
“We like to describe our collection as having breadth rather than depth,” Shelton said. “When it started, we received things from a lot of different people and a lot of different cultures. ... Now the collection process is more formalized, with a leaning toward modern contemporary.
“It’s important to understand that our collection is a teaching collection. The most exposure it gets is through vault visits and faculty bringing students behind the scenes. It changes the way people interact with objects when they’re not behind glass — the art is right there in front of them within arm’s reach.”
The museum and its collection act as a “physical support to the holistic education OSU offers our students,” according to OSUMA marketing and communications coordinator Casey Ihde.
“You can’t have thinkers of the next century without the creative fields,” said Ihde, who has been involved with the museum since 2011, first as an intern and then a full-time employee. “Simply being here allows people to engage with art a little bit more, to become interested and accepting of it. Students and the community are hungry for it now.”
Although the museum has a permanent collection, it doesn’t have a permanent exhibition like many larger museums. This allows its 10 full-time staff to create six to eight distinct shows every year, so there’s always something new for visitors to discover. Some shows feature pieces from the museum’s collection, while others are traveling exhibitions on loan from artists and galleries nationwide.

“Some of the freedoms of being a young museum are getting to explore and find ourselves,” Shelton said. “Some institutions are steeped in tradition and bound by different ties, but we’ve been allowed to experiment.”
Shelton and Ihde noted past exhibitions that included performance artists, immersive projections, blow-up art, extensive community engagement, interactive elements and more. Over the years, the museum’s growing collection and widening network paved the way for shows featuring artists like Robert Rauschenberg, James Rosenquist and Kiki Smith.
In 2017, the museum showcased works from the George R. Kravis II
Collection, which was gifted to OSU the next year.
In 2021, OSU faculty worked with the museum to create the first exhibition of work by Doel Reed, a renowned artist and former OSU professor. And in 2023, the museum curated a Leon Polk Smith show exploring the Oklahoma-born artist’s abstract style alongside 20th-century design.
“Collectively, we have made experiences for our audiences more like a New York moment,” Berry said. “We had to build our facility and staff capacity to handle and present the art at the standard of practice required. ... The success of the museum and the support of the community and campus
made way for the arts to flourish at OSU.”
While there is a long list of museum highlights over the past 10 years, one accomplishment is especially gratifying for the staff: In July 2021, OSUMA received accreditation by the American Alliance of Museums, which is the highest national recognition given to U.S. museums.
“We took the museum from 10% to 100% in nine years by achieving accreditation from AAM. This is no small feat,” Berry said. “We acquired this status through hard work, the quality and collective experience of our team, and the overwhelming support of university leadership and our community.”


The accreditation followed a yearlong self-study by OSUMA, capped by a three-day virtual site visit. During this same period — at the height of pandemic restrictions — the museum continued to provide art access through modified exhibition tours, outdoor art activities and take-home art kits.
“We realized early on, even before the pandemic, that we could provide a free, open space for creativity,” Ihde said, noting that their free Second Saturday events are especially popular with families. “This has taken many forms over the years, developing and growing as we have developed and grown, but we’ve made a conscious effort to get art in front of diverse audiences.
“Not that long ago, if you wanted to go to a museum, you had to go to Tulsa or Oklahoma City. And not only was that Stillwater, it was surrounding towns like Perkins, Yale, Cushing, Ponca City, so we bring it home for people ... and hopefully prompt lifelong learning and appreciation of art.”
With 10 years under its figurative belt, the OSU Museum of Art is looking
toward the future. Although there’s limited capacity for collecting more art — the vault isn’t infinite, and donors have been generous — OSUMA staff see it as “an opportunity to explore the permanent collection and bring in traveling exhibitions that serve the interests of academic programs and the community,” Berry said.
“The provost and the president are working toward strengthening the arts at OSU through collaborative programming and making connections across the curriculum and into the community. We expect the museum will play a large role in this goal to make the arts a permanent feature of the OSU experience.”

Admission is always free!
OSU students serve as tour guides, assistant preparators and occasionally help curate exhibitions.
The museum’s permanent collection can be explored virtually through its Online Collections Database.
Stillwater-born artist
Yatika Starr Fields painted a mural inside the museum during the Postal Plaza Building’s renovation.

OSUMA education staff visit K-12 classrooms and host hundreds of students annually at the museum.
It just takes helping one kid to make a difference.
Those are words Oklahoma State University alumna Stacy McDaniel and her team at Cleats for Kids (C4K) have lived by since the organization’s beginning as a pile of shoes in the McDaniel family’s garage.
“Every time I’ve ever done anything in my life, I’ve always thought, ‘If it can make the difference in the life of one child, it’s worth it,’” McDaniel said. “And for us to think we could make a difference in the lives of over 50,000 children every year is mind-boggling to me.”
McDaniel grew up in Midwest City, Oklahoma, and graduated from Edmond High School in 1983. Her father was raised by a single mother and had his life changed by access to sports.
“My mom’s dad was a basketball and tennis coach back at Central State

College (now the University of Central Oklahoma), so she grew up in the sports world and knew the value of sports,” McDaniel said. “My sport growing up was riding and jumping horses.”
As an Oklahoma native with a family who loved the Cowboys, she said the only school she considered attending was OSU. In the fall of 1983, McDaniel arrived in Stillwater to major in finance.
“From the beginning, my time at OSU was spent learning communication, respect, and valuing others’ opinions and contributions,” McDaniel said. “In addition, the importance of building relationships and relating to others. OSU laid the foundation for everything I’ve done post-undergrad, and I credit the leadership and the administration that gave me guidance.”
While on campus, McDaniel was involved in the President’s Leadership






Council and School of Business Student Council. She was also a member and officer of Pi Beta Phi sorority.
“Participating in philanthropy at OSU fostered an understanding of its value,” McDaniel said. “Seeing firsthand what impact involvement from students could make, not only on the recipients but also on the students taking the opportunity to give back to their community, gave me an appreciation and value on the giving back side of what our mission is now.”
Following her OSU graduation in 1987, McDaniel attended law school at the University of Oklahoma. During that time, she met her husband and future co-founder of C4K, Mark McDaniel. The two were married several years later while Stacy worked in law. Later, she chose to stay home with her three children: Cole, Josh and Meghan.
“When I quote ‘retired,’ I just wanted to be with our kids,” she said. “I tried to work part time after Meghan was born, but honestly, I either needed to hire someone to be me at home, or I could be me, and I decided to be a mom. I did
that for about three years, and then C4K came into our lives.”
C4K was founded in 2011 following a series of events McDaniel now recognizes as a full-circle philanthropy journey. McDaniel’s children were playing basketball at the Pilot Center, a community center formerly located in Oklahoma City for underserved youth.
“The woman who ran the Pilot Center, Lenora Ware, who played basketball at OSU, had the biggest heart,” McDaniel said. “She told my husband and I a story of a local mother of five. Her kids needed shoes to play in the leagues at the center, but purchasing cleats for all five of her kids would make her unable to buy groceries or pay her utilities.”
That was the moment C4K began. The couple started with just a few pairs of cleats in their garage. Within a few months, fueled by donations from parents and children in the neighborhood, C4K outgrew their garage and moved locations.
“A local high school soccer coach reached out for help with 14 varsity
“KIDS WEREN’T PARTICIPATING EVEN THOUGH THEY WANTED TO BECAUSE THEY DIDN’T HAVE SHOES. THESE KIDS ARE OPENING DOORS THEY MAY NOT HAVE BEEN ABLE TO IN PRIOR GENERATIONS, AND THEY’RE GOING TO BE INVOLVED CITIZENS OF OUR COMMUNITY THANKS TO A SPORT THEY MAY OR MAY NOT HAVE HAD ACCESS TO BEFORE A PROGRAM LIKE THIS.”
STACY MCDANIEL, CLEATS FOR KIDS FOUNDER
soccer players,” McDaniel said. “The majority were playing in tennis shoes. One girl had the heel entirely broken off her shoe. We provided cleats to the whole team and socks in their school colors. The following season, the coach had 40 girls try out for soccer instead of 14. That was a light switch moment for us.”
Since then, McDaniel has grown her team to seven employees, five of whom are OSU alumni, all dedicated and passionate about the work and mission of C4K.
“In 2017, we helped launch a program with three Oklahoma City high schools and middle schools to get cross-country and track athletes the shoes they needed,” C4K Deputy Director Allyson Meyer said. “Kids weren’t participating even though they wanted to because they didn’t have shoes. These kids are opening doors they may not have been able to in prior generations, and they’re going to be involved citizens of our community thanks to a sport they may or may not have had access to before a program like this.”
In 2023, C4K served over 464 schools in 65 Oklahoma counties. Mick Wilson, athletic director for Tulsa Public Schools, said C4K has worked with their athletic program for the past four years.
“We have kids in all situations,” Wilson said. “Whether it’s food insecurity or a student who may not have the resources to be competitive in athletics or their schoolwork. It’s our job as educators and adults to try to give kids opportunities beyond what they get at home. We want to remove barriers so all students get an opportunity to be as successful as any other child.”
Millwood Public Schools was one of the first schools C4K started partnering within the Oklahoma City area.
Shannon Hayes, the district’s director of operations, athletics and technology, said his relationship with McDaniel and C4K started in 2014.
“We had kids running track in basketball shoes,” Hayes said. “When the kids stopped having shin splints, the shoes were the best thing they could have received.”
Hayes said students at Millwood have received everything from shoes and cheerleading uniforms to softball and soccer equipment from C4K. By providing equipment to his school, Hayes said high school students participating in sports has increased from under 35% to over 50% last year.
Year by year, C4K has increased the total number of kids served as well as the number of sports equipment distributed significantly. In 2023, Stacy and the C4K team served 52,263 kids with 53,008 pieces of sports equipment, which is a 24% increase in kids served and a 67% increase in sports equipment distributed in 2022. Within the past five years, C4K has had a 97% growth in the number of items distributed and a 148% growth in the number of kids served.
In addition to facilitating the distribution of sports equipment, they also prioritize giving kids the opportunity to contribute to their communities. Most of the equipment kept in the C4K locker room is recycled. It is collected through collection drives, varsity and junior varsity boards, local
businesses, and 30 permanent bin locations in the Oklahoma City and Tulsa areas.
“I feel like I hit the lottery in terms of a boss, mentor and role model with Stacy,” Meyer said. “She started this nonprofit as a dream. I don’t think she knew how much it could grow and the impact it could make. When people ask us for help, our usual answer is yes, let’s see how we can make it happen. That is how she lives her life and the energy in our office comes from her leadership and is shown in the impact Cleats for Kids has made across our state.”


OSU College of Osteopathic Medicine at the Cherokee Nation graduates first class to aid underserved communities



In eighth grade, Mackenzee Thompson wrote an essay about wanting to be a doctor when she grew up. Her decision was solidified after volunteering at a free clinic in college.
“I really understood what a career in medicine meant. It was incredible to me that I could use what I studied and learned to directly impact the health of families for the better, just by offering my time,” said Thompson, a Choctaw Nation citizen who grew up in the small town of Washington, Oklahoma.
Thompson was one of 46 members of the Oklahoma State University College of Osteopathic Medicine at the Cherokee Nation’s inaugural class that graduated in May. She is now completing a family medicine residency with the Cherokee Nation Health System in Tahlequah,

just next door to the medical school she attended.
“OSU-COM at the Cherokee Nation was the perfect fit for me, being both a Native American student and coming from a rural town. Not only was it amazing to be immersed in Cherokee culture, but I felt comfortable living in a smaller town while getting my medical education,” she said. “I had already considered wanting to practice in a Native health care system in the future, so getting my medical education in an environment that would offer the best training to do that was a no-brainer for me.”
In October 2018, Dr. Kayse Shrum, who was then president of OSU Center for Health Sciences, and then-Cherokee Nation Principal Chief Bill John Baker, announced the creation of OSU-COM at the Cherokee Nation — the country’s first tribally affiliated medical school — to be constructed in Tahlequah, the headquarters of the Cherokee Nation.
Two years later, OSU-COM at the Cherokee Nation opened and welcomed its inaugural class. Those medical students are now doctors.
“Tonight, we celebrate the realization of a dream, one that started over a decade ago when I served as president of OSU Center for Health Sciences,” said Shrum, now president of the OSU system, during the May 16 commencement ceremony held at the Mabee Center in Tulsa. “We wanted to expand our efforts to better the health outcomes of rural Oklahomans while also growing the medical school.”
Much like the founding of OSU College of Osteopathic Medicine in Tulsa, OSU-COM at the Cherokee Nation in Tahlequah was established with the mission to train physicians dedicated



to serving rural and underserved populations.
“These graduates, who have completed their training in the heart of the Cherokee Nation, embody the values of service, compassion and excellence that define both the Cherokee Nation and Oklahoma State University,” said Dr. Johnny Stephens, OSU Center for Health Sciences president. “Their journey has been one of dedication, perseverance and cultural understanding. As they embark on their careers, they will carry with them the unique perspective and knowledge gained from this groundbreaking partnership.”
About 35% of the students from the inaugural class matched with rural or tribal residency programs. And 20% of the graduating class from OSU-COM at the Cherokee Nation are Native American from several tribes, including the Cherokee Nation, Chickasaw Nation, Choctaw Nation of Oklahoma and the Seminole Nation of Oklahoma. It’s a substantial percentage compared to the
national average for medical schools, which have Native American student populations of less than 1%.
“As we celebrated the historic milestone of the first class of students graduating from the OSU College of Osteopathic Medicine at the Cherokee Nation, we honored the resilience of our ancestors who faced adversity with courage and determination. Their legacy lives on as this exceptional group of doctors break barriers and forge new paths in health care,” Cherokee Nation Principal Chief Chuck Hoskin Jr said. “Their dedication not only addresses the critical shortage of rural doctors but also increases the representation of Native and Cherokee physicians within our health system and other tribal health systems in this state, ensuring top-notch care rooted in culture for generations to come. Our ancestors would undoubtedly be proud of their achievements, knowing that their perseverance continues to inspire progress and healing in our communities.”
“These graduates, who have completed their training in the heart of the Cherokee Nation, embody the values of service, compassion and excellence that define both the Cherokee Nation and Oklahoma State University.”
Dr. Johnny Stephens, OSU Center for Health Sciences president

A groundbreaking ceremony for the medical school was held in spring 2019, followed by a topping-off ceremony later that fall. The emergence of the COVID19 pandemic, along with building supply chain issues in 2020, delayed the opening of the 84,000-square-foot medical school building until January 2021.
It hasn’t been an easy journey for the inaugural class, which started coursework in August 2020. That first semester, they had to attend many courses virtually due to the pandemic, and any required in-person classes were held at the Cherokee Nation Outpatient Health Center or W.W Hastings Hospital until the building was complete.
“The first semester of medical school is difficult. Compound the stress of moving, forming new relationships, learning a high volume of complex information during a global pandemic, and you begin to understand the challenges faced by the class of 2024,” said Dr. Natasha Bray, OSU-COM at the Cherokee Nation dean. “The class of 2024 demonstrated resilience and leadership. They developed deep friendships and a culture of support both in the learning environment and the community. They developed a deep, and I hope enduring, appreciation of the role of physician in service.”

Ashton Glover Gatewood, an enrolled member of the Choctaw Nation and descendent of the Chickasaw and Cherokee nations of Oklahoma, was working as a nurse and health care administrator at the Oklahoma City Indian Clinic when she applied to be part of the first class of medical students on the new Tahlequah campus.
“I loved being a member of the inaugural class. We went through a lot as a class. I think we had a unique set of challenges, but we really grew together; we uplifted each other, and we helped each other. Our faculty, staff and facilities make this a premier medical school, especially for students interested
in primary care, rural health and tribal health,” said Gatewood, runner-up for National Student D.O. of the Year in 2022. “I also feel a responsibility to represent my tribe. I hope that my story can inspire others to continue pursuing their dreams, especially Native students and women who may not have many mentors in their communities.”
For Thompson, being a part of the inaugural class meant connecting with her heritage.
“I grew up outside of the Choctaw Nation and my family didn’t carry many Choctaw traditions, so attending OSU-COM at the Cherokee Nation truly brought me closer to my heritage and allowed me to connect with other students like me,” she said. “I learned so much from my other Native American colleagues and finding those similarities in our journey further added to the feeling of community I felt in Tahlequah.”
Bray said students in the inaugural class completed an immense number of community service hours, including being trained and then administering COVID-19 vaccinations through Cherokee Nation Health Services, building homes with Tahlequah Habitat for Humanity, supporting Tahlequah’s Help in Crisis nonprofit organization, as well as serving many other community groups and organizations.
“I cannot adequately express my pride and admiration for the class of 2024. Their selfless service to each other and the communities we serve is admirable. Watching their growth and development of professional identity has been a deep honor,” she said. “I know they will do such meaningful and amazing things in their professional lives and will make a deep impact on the communities they will serve.”
Stephens said watching the inaugural class walk across the
graduation stage was the culmination of a decadelong pursuit to build a sustainable physician pipeline for rural and underserved Oklahoma.
“I’m so impressed by their achievements, and I’m looking forward to the positive impact they will undoubtedly have on the health and well-being of the communities they serve,” he said.

Scan the QR code for more information about the OSU College of Osteopathic Medicine at the Cherokee Nation.
The text above and on pages 62 and 67 are Cherokee translations of both the headlines for this article and the full Osteopathic Oath, which is also on the magazine’s cover.

OSU medical courses ensure all populations are receiving care
The Oklahoma State University College of Osteopathic Medicine was founded more than 50 years ago with the mission to educate and train osteopathic physicians to meet the health care needs of rural and underserved communities in Oklahoma.
OSU-COM continues to meet that mission. It was ranked No. 1 in percentage of graduates practicing in Health Professional Shortage Areas and No. 10 in graduates practicing in rural areas from “U.S. News & World Report’s” medical school rankings in 2023. In fact, about 50% of OSU-COM graduates are practicing in Health Professional Shortage Areas.
“I’m so proud of our institution, our graduates, our faculty and staff for their unwavering commitment to this mission,” said Dr. Johnny Stephens, OSU Center for Health Sciences president. “By emphasizing
innovation and passion for community, OSU-COM produces graduates eager to work in these medical deserts.”
One of those innovations is developing three specific medical education tracks that OSU-COM students choose to enroll in that focus on health care in rural, tribal and urban and underserved communities.
OSU-COM’s mission to produce primary care physicians for rural Oklahoma is critical as the state is challenged by continued shortages of primary care physicians. Seventyfive of Oklahoma’s 77 counties are considered a HPSA.
Students can also participate in the optional Global Health Track, which includes international trips to countries and regions where primary care medical professionals are in need.

Successful Rural Medical Track students are mission-focused on serving rural communities and passionate about improving disparities of care. They want to implement positive changes and work on research projects addressing rural health care issues. They often grew up in a rural community and are interested in returning home, or to a town a lot like it, to practice medicine after graduation.
Benefits of the Rural Medical Track:
Work with clinical education staff to develop personalized plans of study that match the student’s specific practice interests.
Hands-on training and experience with physicians who understand the challenges and limited access to medical services in rural communities.
Opportunities to experience and collaborate on new health care delivery models, such as telehealth and virtual medicine.
“Practicing in a rural community aligns with my roots and my passion for helping people in small towns. Growing up in Blanchard and seeing the health care challenges faced by my community, I am committed to making a difference. I want to serve both the rural and tribal communities, ensuring they have the health care access they deserve.”
Holden Mayfield, OSU-COM Class of 2025

Students in the Tribal Medical Track are interested in serving tribal and rural communities and have a passion for improving the lives of Native American patients and treating health disparities in Indigenous populations. They are attracted to conducting research aimed at tribal health care concerns and, following their graduation, want to return to their tribal or rural community to practice medicine.
Benefits of the Tribal Medical Track:
Unique training and work experience with doctors who know the challenges and benefits of practicing in tribal health systems.
Special medical rotations reserved only for Tribal Medical Track students at tribal clinics or hospitals during their third year of medical school.
Learn about Indigenous medicine, health disparities among Native American populations and career opportunities in tribal health care.
“One of the best aspects of the Tribal Medical Track is learning from different tribal facilities. There is so much we have in common but also differences between our nations. One overarching theme is the love that we share for our communities and hope for the future of health and wellness in Indian Country.”
Ashton Glover Gatewood, OSU-COM Class of 2024
Medical students interested in serving a diverse population and having a drive to improve the health and wellness of patients in urban areas can choose to enroll in the Urban Underserved Medical Track. They are interested in practicing primary care specialties such as family medicine, internal medicine, pediatrics, obstetrics and gynecology. Physicians who practice emergency medicine, general surgery, psychiatry and behavioral health are also in need in underserved communities.
Benefits of the Urban Underserved Medical Track:
Real-world experiences and training with doctors and health care professionals who understand the benefits and challenges of working with urban and underserved populations.
Specialized rotation reserved for Urban Underserved Medical Track students at an urban clinic or hospital during their third year of medical school.
Learn about racial, ethnic, socioeconomic and gender health disparities and receive training to treat patients in a free clinic setting.
“Practicing medicine in an urban area involves providing care for a diverse population. Having a physician workforce that is equally as diverse as the population being served is one way health equity may be advanced.”
Merhawit Ghebrehiwet,
OSU-COM
Class of 2025
The Global Health Track is offered to medical students interested in global medicine and international outreach. The curriculum allows students to explore the challenges and procedures of delivering health care services in other countries. Participants gain experience working in a country with different medical, economic, environmental and cultural factors that influence quality of care, which fosters a more global perspective on medicine.
Benefits of the Global Health Track:
Medical students enhance their physical examination and diagnostic skills under the supervision of licensed health care professionals.
Expose participants to common acute and chronic conditions, as well as emerging and unusual diseases significant to global public health.
Provides an opportunity for students to participate in humanitarian outreach and promote the tenets of osteopathic medicine worldwide.
“You gain perspective on what your patients have been through, but also what you have that you take for granted. You also reach a level of empathy you didn’t know you had. I don’t think a healthy lifestyle should only be available for those who have access to it. It’s why I went into medicine, to reach people who are hard to reach.”
Ryan Emmett, OSU-COM Class of 2025
$6.75 MILLION GIFT TO DEPARTMENT OF PHILOSOPHY TO ADVANCE ETHICS AND CRITICAL THINKING AT OSU

If we approach our global challenges with deep ethical understanding and critical thinking skills, there is no problem humanity cannot solve.”

Dennis Heinzig yearned for more.
Growing up in Prague, Oklahoma, his environment pressured him to think a certain way and adopt prescribed beliefs. He was looking for answers, and they wouldn’t be found there.
So, Heinzig ventured out into a world that was much larger and different than he expected. One that did not fit the perspective he started with, nor for which he was prepared. It’s where he found philosophy — where his quest for a broader understanding of truth and wisdom really began.
“What philosophy did for me was take the blinders off conceptually,” Heinzig said. “It allowed me to begin to think more objectively about life’s important questions. By going beyond what I was taught one must think or believe, I began to discern what is true and ethical and then live accordingly.”
Heinzig, 63, and his wife, Iona McMillan, have benefited immensely from studying philosophy, and the couple wants as many Oklahoma State University students as possible to have the same opportunity.
In pursuit of that goal, Heinzig and McMillan made the largest donation ever to the OSU Department of Philosophy.
The $6.75 million gift will establish an endowed chair and fund for both Ethics and Critical Thinking as well as an endowed general fund for Philosophy. It has also funded the Heinzig & McMillan Endowed Scholarship for Ethics and Critical Thinking.
The gift is one of the 10 largest ever made to any higher education philosophy program.
“We are deeply grateful for Dennis and Iona’s visionary commitment to advancing critical thinking and ethics at OSU,” department head Scott Gelfand said. “This transformative gift will empower our faculty and students to engage in rigorous inquiry, ethical reflection and meaningful action, contributing
to the cultivation of ethical leaders and responsible citizens.”
Heinzig leaving his hometown opened his eyes to the world. For many, that journey begins when they arrive at college. It’s their first time living away from home environment and being positioned to make decisions entirely on their own.
These formative years are critical in a person’s development, making it vital to gain these skills before time is more limited with a career or family.
“Philosophy can help you realize that maybe answers you have memorized are not authentically your answers,” McMillan said. “Part of the college experience is
figuring out, what do I believe? What do I think is right and wrong?
“It is a really important time in the formation of a person’s core values that they will use as their life’s compass, determining how they navigate issues they will encounter throughout their life and in any profession.”
Not only will the gift impact philosophy majors, but it will also promote the importance and relevance of the subject to the general student population. Even a little exposure to philosophy, such as a minor, a certificate, or simply taking a single class, can be incredibly valuable for their life and career.
Ethics and critical thinking play a prominent role in OSU’s strategic plan and mission to become the nation’s preeminent land-grant university.
“At OSU, our ideal graduate demonstrates professional preparedness, engaged citizenship, ethical leadership and personal responsibility,” OSU President Kayse Shrum said. “Each of those qualities has roots in philosophy, and when demonstrated, will serve our landgrant mission by equipping graduates to positively impact their communities. Dennis and Iona’s generosity with this historic gift will help us ensure our graduates are prepared to make a difference in the world.”
The couple has been involved with multiple charities over the years, but it was McMillan’s idea to think about making an impact at OSU, where Heinzig studied philosophy in the master’s program from 1985 to 1987. He also taught a section of the Philosophy of Life course, a class still offered at OSU. “After a lifetime of contributing to many different causes, we came to the
conclusion that the best thing we can do for generations that follow us is to equip them with the tools to help navigate the increasingly complex issues they are and will be facing,” said McMillan, a native of Brazil.
In Stillwater, Heinzig met an immensely influential person in his life — philosophy professor Ed Lawry. Lawry was always supportive and approachable, even helping Heinzig on his own personal time. Most importantly, he taught his students to think about philosophy as applicable to real-life issues.
Philosophy is often viewed as an abstract thought exercise. However, its real value is in how it can be applied to everyday life. The application of philosophy guided Heinzig throughout his 30-year business career.
“As an employer, I found it much harder to train someone to approach business decisions with ethics and critical thinking than it was to teach them knowledgebased job skills. I also found that if the former was lacking, it was generally a waste of time to do the latter,” Heinzig said. “To think carefully and be a good person — those two qualities are required to navigate life’s challenges for the good of oneself and all others.”
In the spirit of Lawry, Heinzig and McMillan hope their gift will help students and faculty appreciate the importance and relevance of philosophy, which has a unique role to play in society.
The lessons learned can be applied to any field and will hopefully have a positive effect on others around them as well. To that end, the department is offering
a new minor: The Art and Science of Critical Thinking.
“We hope our contributions will equip people with critical thinking skills and a deeper ethical understanding that will in time make a meaningful difference in our world,” McMillan said. “Our intention is to disseminate the benefits of philosophy as broadly as possible, equipping new leaders with the tools and understanding required to grapple with a rapidly changing world.”
Advances in technology, medicine and more are coming at a rapid rate. While much of this progress can make the world better, easier and healthier, it can also cause catastrophic damage if the
consequences and ethical implications are not considered.
With the funding from this gift, OSU will help foster an environment for students to think proactively. Heinzig referenced the Iroquois tribe, which believes in considering the impact of any big decision seven generations into the future.
“Philosophy is more important than ever before,” Heinzig said. “Today, everything is knowledge based, and knowledge is increasing at an incredible speed. But the problem is our wisdom hasn’t kept up with it.
“We need to double down on the wisdom and the ethics to manage the knowledge that is exploding. Knowledge without wisdom and ethics is reckless and dangerous.”
Philosophy and philanthropy share the same root word, phileo, or brotherly love. In Greek, philosophy means the love of wisdom, while philanthropy means the love of humanity.
Heinzig and McMillan believe the two are intrinsically intertwined, and that, with conflicts raging across the globe, OSU can play a part in making the world a better place.
“OSU is a very special community and has the right mission and environment to show how philosophy is just as impactful and relevant as agriculture, technology or energy to our lives and our future,” Heinzig said. “If we approach our global challenges with deep ethical understanding and critical thinking skills, there is no problem humanity cannot solve.”
To learn more about how you can make an impact at OSU, visit OSUgiving.com.

Oklahoma State University is more than its Stillwater campus. Now, it’s showcasing all the system has to offer to a prestigious group of donors.

On April 29, the OSU Foundation hosted members of Heritage Society for its annual celebration — this time with a change of scenery. Attendees received an in-depth look at the impact being made at the OSU Center for Health Sciences in Tulsa.
These Campus Spotlight events for Heritage Society will be held every other year at a different campus, with gatherings in Stillwater in between.
“While we are all familiar with how special the Stillwater campus is, these events will be a wonderful opportunity to shine a light on the incredible things happening at all our campuses,” said Derrick Davies, assistant vice president of
gift planning at the OSU Foundation. “Our hope is that we can introduce donors to new things across the OSU system by hosting Heritage Society at a branch campus every other year.”
Heritage Society consists of alumni and friends who have made a commitment to OSU by will, revocable living trust, life insurance, life-income gift, retirement account designation or other deferred gift arrangement.
The group has nearly 2,000 members, who cumulatively documented more than $45 million in gifts to OSU across a vast range of areas during the past fiscal year.
“Our Heritage Society members continue to leave an indelible mark at Oklahoma State University, including here at OSU-CHS,” said Dr. Johnny Stephens, OSU-CHS president. “Their support has changed what is possible for countless students who will go on to serve our state, nation and world as medical professionals.”



At the event, members received tours of the Tandy Medical Academic Building and the adjacent North Hall. Student ambassadors led the tour groups, lending their expertise, answering questions and sharing firsthand experiences using the facilities.
Medical student Harrison Smith is a prime example of how Heritage Society’s impact is felt at OSU-CHS. He is a recipient of the Betty Louise Conrad Early Admissions Scholarship, which was established with an estate gift.
After Smith suffered a major leg injury playing sports in high school, he realized becoming a doctor seemed like the perfect job.
“Going through those surgeries was my first exposure to medicine, and I was amazed by the technical skill and relational aspect my doctors showed,” Smith said. “Going into undergrad, I had a strong conviction to serve those in need and a real curiosity for the masterfully designed human body.”
Despite his interest, Smith entered OSU as a finance major because he was unsure about getting into medical school. But he soon realized he needed to exchange spreadsheets for a white
coat. And to him, OSU was the perfect place to pursue his dream.
“OSU really emphasizes treating the whole person — the body, mind and soul,” Smith said. “The curriculum and the faculty reflect this mission. Although my experience thus far has had its fair share of ups and downs, the people and the purpose here make it worth the effort.
“I know one day it will be actualized when we are caring for patients in a way that conveys true care and humility.”
Although he isn’t sure yet what specialty he will pursue, Smith wants to be a physician who cares for the whole person and strives for excellence.
Medical school isn’t easy, and before enrolling, Smith was also intimidated by the cost. His scholarship has removed that extra layer of stress, and he’s extremely thankful for the generosity of donors like those in Heritage Society.
“I know firsthand how impactful estate gifts are on OSU students like me and the true blessing they are to us,” Smith said. “Scholarships relieve some of that stress so we can focus on becoming the best doctors we can be.”
To learn more about making a planned gift at OSU, contact Derrick Davies at ddavies@ osugiving.com or 405.385.5661.



FALL LEISURE LEARNING CLASSES:
Sept. 19-21, 2024
Doel Reed Center in Taos
STUDENT EXHIBITION
Sept. 19-28, 2024
Modella Art Gallery, Stillwater
2024 SMELSER VALLION VISITI NG ARTIST MEGGAN GOULD LECTURE AND STUDENT EXHIBITION PRESENTATION
Sept. 26, 2024
Modella Art Gallery, Stillwater



The OSU Doel Reed Center in Taos extends Oklahoma State University’s reach to culturally rich northern New Mexico, offering students a studyabroad experience without having to leave the country. This unique learning experience has a transformative impact on each student, no matter their area of study. Many students depend on scholarships to take advantage of the educational opportunities available at the Doel Reed Center. Academic programming can only be expanded with additional support, affording more students a chance to participate in these amazing programs.
“Without the generous scholarship I received, I would never have been able to have this experience,” said Jahania Wright, a recent graduate of OSU. “It allowed me to explore a new culture and delve into new artistic and intellectual pursuits that aided me in my understanding of my field. While learning about arborglyphs in a classroom at OSU would have been interesting, it simply does not compare to the trip to Taos and having classes at the Center.”
To learn how you can help support the Doel Reed Center, contact Jayme Ferrell at jferrell@osugiving.com or visit OSUgiving.com/DoelReed. To read about all the Doel Reed Center has to offer, visit doelreed.okstate.edu.

OSU GRADUATE TURNS IDEA INTO POTENTIALLY LIFESAVING BUSINESS WITH RIATA CENTER SUPPORT
William Colton had a lifechanging conversation when he wandered into the Riata Center inside the Spears School of Business as an Oklahoma State University sophomore.
Colton typically passed the new, crescent-shaped Business Building while walking to his microbiology and molecular genetics classes during the fall 2018 semester. This time, he had a reason to step through the glass doors and approach the Allen Family Genius Bar, where students with business ideas seek expert advice.
OSU entrepreneurship professor David Thomison was behind the counter that day. When he heard Colton’s proposal, the Spears Business faculty member with an MBA from Harvard quickly realized his potential.
“I’ve had students constantly walk up with ideas, but they’re not usually of this scientific magnitude,” Thomison said.
It reads like the beginning of a groan-inducing dad joke: a microbiology student walks up to a bar where ideas are served in lieu of drinks. But it was a serious light-bulb moment for Thomison, who immediately asked Colton if he had considered participating in business plan competitions. Since then, Colton has won thousands in prize money, received Mayo Clinic recognition and grown from a young scientist into a business founder who could transform health care.
Colton, the chief executive officer of Paldara Pharmaceuticals, invented a hydrogel coating that prevents bacterial infection, potentially saving lives worldwide.
Thomison and Spears Business students taught him how to market it.
Inventors like Colton make brilliant discoveries, but to truly change the world, these concepts need business strategies behind them. OSU has multiple routes to make this happen. Some inventors go through The Innovation Foundation at OSU, which
translates campus research into marketable products and services. As the CEO of a company independent from OSU, Colton took a different path, still with the support of his alma mater.
“You usually only hear about this at Ivy Leagues,” Colton said. “So, it’s really cool to have that kind of ecosystem in Stillwater.”
Through business plan competitions and OSU’s Creativity, Innovation and Entrepreneurship Scholars program, Thomison equipped Colton with the business savvy to carry his brain power far beyond the campus lab where his findings began.
Colton learned to use his imagination at an early age.
As a child in Bellaire, Texas, he and his father made up stories about a kingdom called Paldara. Years later, Colton bestowed that majestic name upon a different product of his creativity. Paldara Pharmaceuticals is the parent company of an invention that, for vulnerable hospital patients, could make the difference between life and death.
For Colton, this mission is personal. His grandmother died only a couple of months after developing an infection related to hip replacement surgery, and he strives to protect others from the prevalence of antibiotic-resistant bacteria.
“It’s really an act of compassion in trying to make sure that we keep patients safe,” Colton said.
The ideas began flowing at OSU in Dr. Matthew Cabeen’s lab. When an undergraduate Colton developed a gel harnessing the power of bacteriophages — naturally occurring viruses that attack harmful bacteria — he knew a large market existed for his product.
But he didn’t know how to commercialize the invention.
This is where the Riata Center worked its magic. After years of working with Spears, Colton explains his technology easily and confidently

“YOU USUALLY ONLY HEAR ABOUT THIS AT IVY LEAGUES. SO, IT’S REALLY COOL TO HAVE THAT KIND OF ECOSYSTEM IN STILLWATER.”
WILLIAM COLTON, PALDARA PHARMACEUTICALS CEO


as if he’s delivering a pitch on “Shark Tank,” using analogies that resonate with people outside the scientific world. Although the earliest applications of his product have focused on catheters, the gel is intended for various medical uses.
“Think of it as a new version of Neosporin,” Colton said. “You’re developing a new gel coating for just about anything you’re going to use in or around your body — wound bandages, urinary catheters, implants — and we apply that gel coating over that device. That essentially protects you from infection for seven to 10 days after treatment, specifically from drugresistant bacteria.”
Unlike Neosporin, Colton’s gel doesn’t rely on antibiotics. The bacteriophages target harmful bacteria but protect the microbiome that benefits humans, he said. Imagine microscopic superheroes swooping into a city to fight villains while keeping the citizens safe.
It happens before the villains have a chance to wreak havoc. Rather than curing infection, Colton found a way to prevent up to 99% of pathogenic bacteria from causing it in the first place, another distinctly appealing quality of his hydrogel.
Thanks to Colton’s innovative approach, his invention has 15 unique patent claims as he works with the
United States Patent and Trademark Office to secure legal protection. Thomison recognized this originality when he met Colton at the Genius Bar.
Thomison has a reputation in the Business Building as an entrepreneurship wizard, but his path started quite differently.
Before he advised small business owners in the private sector or earned the distinction of OSU’s George Kaiser Family Foundation Endowed Chair in Entrepreneurship, Thomison wanted to be an engineer. He holds a bachelor’s degree in industrial engineering and management from OSU.
“I went into engineering because I love to create and to build things,” Thomison said. “Then I figured out the most challenging thing in the world to build is a new business.”
For over 10 years, Thomison served as senior vice president of the client services group at i2E, an Oklahoma-based business development organization. With his interdisciplinary background, he knew the pieces Colton needed to make his vision work.
But how did a microbiology and molecular genetics student find himself face-to-face with Thomison at the Genius Bar in the first place?
In a serendipitous encounter at an out-of-state medical conference, a patent attorney encouraged Colton to bring his hydrogel idea to OSU’s Riata Center for Innovation and Entrepreneurship. Colton doesn’t know the attorney’s name or how this person knew about the Riata Center, but he took the advice.
“It was great because I could just walk in and go up and talk to someone,” Colton said. “David really taking it seriously from the get-go helped to give me that validation, and it made me comfortable.”
Thomison first conducted an independent study with a team, including Colton, to present the hydrogel invention through an entrepreneurial lens.
Years of hard work followed, and Colton gained real-world experience

OSU graduate William Colton developed a hydrogel to prevent bacterial infections such as catheter-associated urinary tract infections.
through business plan competitions, delivering sales pitch after sales pitch with Thomison as a coach. They further collaborated when Colton took Thomison’s CIE Scholars course as a graduate student, partnering with fellow scholarship recipients across campus with the unified goal of refining Colton’s research into an appealing commercial product.
“You’re seeing the polished William, not the William out of the gate with the first one,” Thomison said. “He’s always had an outgoing personality. But he would sell science and features instead of value first. What people care about is, ‘What’s the benefit?’ not, ‘How do you achieve it?’ He’s learned to flip it from a business perspective and lead with the value, not the technology.”
With each competition, Colton realized Thomison was one of many who believed in this value.
Colton’s hopes dwindled as he heard competitors’ names announced for third and second place at the Love’s Cup in 2019. He realized his team might not receive an award, but his debut business plan competition could at least serve as a trial run for his pharmaceutical startup.
Then came the first-place reveal. Paldara Pharmaceuticals won its division, receiving the $20,000 grand prize. The Oklahoma City-based event served as a launchpad for Paldara, which
then reached the top 15 at Princeton University’s competition and the top 18 at Rice University.
“It really, really changed my perspective on what I was doing and really focused my mindset on building my business,” Colton said.
It’s a difficult, drawn-out process to create a sustainable company, but Colton has the skills to navigate opportunity and uncertainty. His keen grasp of science and business stands out to people like John Nickel, assistant director of Cowboy Technologies. Nickel’s Innovation Foundation office in Stillwater faces Meridian Technology Center, where Colton works on his invention in a lab reserved for him.
“There is just a tenacity,” Nickel said. “There’s something very different about what he’s trying to do. He has the technical piece, and he also has this sales-entrepreneurial (piece) at the same time, which is pretty rare.”
Medical professionals recognize the vast potential of Colton’s ingenuity, too. While working with Thomison, Colton and his team conducted more than 100 interviews with hospital staff about Paldara, receiving what Colton called “overwhelmingly positive feedback.” The company was selected this March for the prestigious Mayo Clinic and Arizona State University MedTech Accelerator program, where Paldara won a pitch competition and received $5,000 worth of legal services.
The honors are stacking up, and Colton can tap into Paldara’s full potential once he reaches a gamechanging step: approval from the U.S. Food and Drug Administration. While working toward that goal, Colton is also taking a One Health approach, partnering with OSU’s College of Veterinary Medicine to gauge the effectiveness of his product in animals.
As Colton continues his discoveries, he needs capital. The funding from business plan competitions and investors has carried Paldara a long way, but there’s more to go. As Thomison knows, starting a business is a leap with risks and rewards.
“He’s either going to be bankrupt in two years, or he’s going to be incredibly wealthy in two years,” Thomison said. “But he’s in the game. And I would bet on him.”
Thomison took a chance. After their momentous meeting, Colton gained the bravery to do the same.
“It really helped to give me a foundation of confidence in how I would go and pitch this business and to believe in myself and what I was developing,” Colton said. “I wouldn’t be here without the support I had from David Thomison and people in the Spears School of Business. It takes a team. It’s much more than just one person. Having that kind of support is what got me to where I am today.”

Cowboy Enterprises is an integral part of The Innovation Foundation at OSU, designed to promote entrepreneurship and facilitate the transformation of innovation within the university and community into viable businesses.
It provides the right assistance and funding resources at the right time for students, faculty, alumni and the community to develop and launch their business ideas, contributing to economic development and diversification in Oklahoma.
Helping teams define their unique value and target customers to achieve product-market fit through the NSF I-Corps program.
Providing commercial grant assistance for energy, aerospace, agriculture, and One Health technologies in northeast Oklahoma, focusing on SBIR/STTR grants and other opportunities, supported by the Economic Development Agency’s University Center’s grant.
Providing access to experienced business professionals in technology fields for insights, guidance, and connections to develop successful business models, market strategies and growth plans.

A key component of Cowboy Enterprises is the Cowboy Innovation Accelerator. This program specifically focuses on accelerating the growth of startup ventures inside and outside of OSU, such as Paldara LLC. It offers a structured environment where aspiring entrepreneurs can refine product/ market fit, identify and procure translational funding and prepare for market launch and venture capital raise needs. Another critical component of Cowboy Enterprises is Cowboy Technologies LLC, the for-profit venture capital arm of The Innovation Foundation at OSU. Cowboy Technologies LLC makes returns-based investments in internal OSU technology development projects and growth startups affiliated with OSU, including those licensing OSU intellectual property.
“At the Innovation Foundation, we believe entrepreneurship and collaboration are the cornerstones of economic growth and innovation,” said Elizabeth Pollard, CEO and president of The Innovation Foundation. “The Cowboy Innovation Accelerator exemplifies this by providing OSU and the community with the assistance and resources needed to transform groundbreaking ideas into successful, growth businesses.”
The Accelerator provides a comprehensive suite of resources and support.

Providing essential business support for startups navigating the complexities of formation, registration and initial operations setup.
Creating dynamic opportunities for learning and networking, enabling innovators and entrepreneurs to connect with peers and subject matter experts.
Bridging the gap between industry and OSU by creating alignment between startups’ needs and OSU applied research capabilities.










































































Gallagher-Iba Arena is no stranger to hosting the extraordinary.
But this time, its audience gathered not to witness athletic feats but to celebrate a group of Oklahoma State University’s most dedicated supporters.
On April 12, the Oklahoma State University Foundation held its biannual event to honor OSU’s Proud & Immortal Society. The elite group is made up of individuals, companies and foundations whose cumulative giving to OSU has reached at least $1 million.
“I look around this room, and I’m moved by the magnitude of your generosity,” OSU Foundation President Blaire Atkinson said. “When I see
your faces, I’m reminded of your stories and your passion for this great university. I can’t help but think about the thousands of lives you’ve touched, and I’m humbled to know that each of you here tonight cares deeply for our students.”
Eddie Sutton Court was transformed to host the black-tie gathering. With string lights overhead, the elegant setting featured live music from OSU alumni and was emceed by News 2 Oklahoma’s Brodie Myers, another Cowboy alumnus.
The number of donors who have contributed $1 million or more to OSU has grown exponentially since the turn of the century. In the university’s first 110 years, OSU had accumulated 50 $1 million



“This group is the heartbeat of Oklahoma State University. So much of what we can do begins with your passion and commitment to OSU.”
DR. KAYSE SHRUM, PRESIDENT OF OKLAHOMA STATE UNIVERSITY
donors. By the time Proud & Immortal launched in 2015, that number had grown to 333.
After continuing to gain momentum over the last nine years, the group now boasts more than 500 members. Its comprehensive giving has totaled $2.8 billion.
“The growth of our Proud and Immortal Society is nothing short of remarkable,” Atkinson said.
At the event, 66 new members were inducted into the society, receiving a custom-made, hand-crafted rosette in honor of their generosity. Sixty-two existing members were also recognized for their elevated giving.
Attendees heard from OSU President Kayse Shrum, Atkinson, donor Ross McKnight and OSU Foundation Trustee Joe Eastin.
“The Proud & Immortal Society truly defines the Cowboy culture,” Eastin said. “OSU is such a special place, and it takes a special kind of commitment and generosity to uphold that
standard. You all are an inspiration to the whole Cowboy family.”
The night kicked off with the unveiling of an updated Proud & Immortal Society donor wall in the Student Union outside the theater. For students who walk past it every day, the tribute will serve as a permanent reminder of the individuals who have shaped OSU’s legacy.
“The great thing about the Cowboy family is we accomplish big and bold things, and we do it one student — and one heart — at a time,” Dr. Shrum said. “This group is the heartbeat of Oklahoma State University. So much of what we can do begins with your passion and commitment to OSU.”
To learn more about how you can make an impact and create a legacy at OSU, visit OSUgiving.com.

SEPTEMBER 17 & 18
Did you know that 20-25% of OSU students identify as first-generation?
First-gen students come from families where neither parent nor guardian has a four-year degree from a college or university. OSU is committed to supporting these individuals, and you can make an impact with a gift to Cowboys United for First-Gen Students.
The campaign will invest in:
First-generation peer mentor programs that focus on academics, campus engagement and overall well-being. Scholarships for first-gen students to assist in their retention and persistence at OSU.
Services that connect first-gen students’ parents and family members to campus so they can help guide their students through the college experience.
TO LEARN MORE ABOUT COWBOYS UNITED FOR FIRST-GEN STUDENTS AND TO MAKE A GIFT, VISIT OSUgiving.com/CowboysUnited.
The Boone Pickens Legacy Experience will open this fall in the West End Zone complex of Boone Pickens Stadium in partnership with Oklahoma State University and the Boone Pickens Foundation.
The exhibit honors Pickens and his unwavering dedication to OSU. Construction on the 10,000-squarefoot installation, which was privately funded, began in early 2024.
One floor contains detailed recreations of settings significant to Pickens’ life, including his childhood home in Holdenville, Oklahoma, his office and a replica of his 1955 Ford station wagon, which he used as a mobile office during the early days of his business career.
Pickens, a business titan, believed that the most important life lessons were learned growing up in a small Oklahoma town and further refined during his time at OSU. The installations share stories from his extraordinary life through a vast collection of artifacts, gifts, awards, mementos and memorabilia accumulated throughout his lifetime.
The Boone Pickens Legacy Experience was created by Bostonbased exhibition design firm Amaze Design, led by founder and creative director Andy Anway. Anway is known for his extraordinary work designing engaging visitor experiences, including the Perot Museum of Nature and Science, Bob Dylan: Electric at the American Writers Museum and the Sue S. Bancroft Women’s Leadership Hall.





Donna Koeppe, Oklahoma State University Foundation vice president of administration and treasurer, has retired after 40 years of service to OSU. She is the longest tenured employee in the Foundation’s history.
“I’m a blessed woman, and I could not have asked for a better career,” Koeppe said. “I received so many opportunities, and people continued to believe in me and mentor me. It’s magic here (at the Foundation). There’s such a culture of caring, hard work and a commitment to doing great things.”
Koeppe has been a key member of the Foundation’s leadership team and
an important part of the Foundation and OSU’s success. The Foundation’s annual financial impact has grown exponentially under her leadership.
She earned her bachelor’s degree in accounting from OSU in 1983 before starting as a senior clerk for the Office of University Development a year later.
In 1994, Koeppe served as the Foundation’s financial services director when the organization launched its first comprehensive campaign, Bringing Dreams to Life. She played an integral role in the success of the campaign, which raised $260 million, more than doubling its goal.
Koeppe also helped lead the way during OSU’s second comprehensive campaign, Branding Success, which raised more than $1.2 billion.
“It’s hard to put into words the 40 years of impact Donna has had
at the Foundation,” OSU Foundation President Blaire Atkinson said. “She has positively impacted the lives of countless individuals and seemed to seamlessly balance being a genuine friend and mentor, mother, wife and successful businesswoman. The Foundation has experienced remarkable growth thanks to Donna and her leadership.”
Dawn Barnard succeeded Koeppe in her role at the Foundation. Barnard came to OSU from Washington State University, where she worked for the past 18 years. She most recently served as the associate vice president and chief financial officer in advancement services.
After nearly 30 years on the job, Oklahoma State University Police Chief Leon Jones retired July 31.
Jones started with the department in October 1994 — his first job as a law enforcement officer. He worked his way up, becoming chief of police in 2017. As a patrolman, Jones was asked to start the first community policing program on campus, as well as the bike patrol program, which took officers out of patrol cars and made them visible and accessible.
As chief, he started the Core Campus Patrol Division, which puts officers on foot and bicycles in the most populated areas of campus during peak hours — locations hard to access by car like the Student Union and Edmon Low Library. OSUPD also implemented the liaison program, which pairs officers with athletic teams and student groups.
A consummate Cowgirl who has shown unwavering devotion to Oklahoma State University, Anne Greenwood will join six others in the Oklahoma Hall of Fame’s 97th class, which will be inducted at a Nov. 14 ceremony at the Oklahoma City Convention Center.
“The honorees included in this year’s class are shining examples of Oklahoma’s excellence and commitment to serving others,” said Shannon L. Rich, Oklahoma Hall of Fame president and CEO. “Their remarkable achievements and unwavering dedication to their fields serve as a testament to the unlimited potential that Oklahomans provide, inspiring generations to come.”
Jones never expected to be a police officer, let alone one with 30 years under his belt.
“I didn’t think I would be at OSU for more than 20 years — but looking back and coming up on 30 years — I feel like I’ve done my part,” Jones said. “I’ve enjoyed every minute of it. It’s time for someone else to have the opportunity to step up and run this great department I’ve been in charge of for the past eight years.”
OSU President Kayse Shrum said Jones has served an important role with the campus community.
“It has been a privilege to work with Chief Jones. He has a servant’s heart and I personally know of instances where he has gone above and beyond to meet the needs of students,” she said. “He embodies the Cowboy Code, always willing to stand for what’s right. Over the course of his career, he has made campus a better place.”
After retirement, Jones plans to turn his knowledge in criminal justice and law enforcement into a teaching

position with Meridian Technology Center for fall 2024.
“I want to make sure the place is ready to go for the next person,” he said. “I want to make sure it’s still running smoothly and is set for success.”
An external search is being conducted to find Jones’ successor.
Greenwood served in several roles during her 30-year corporate accounting career. After retirement, she turned her passion for philanthropy into a second career, focusing on improving access to higher education and elevating the performing arts.
Greenwood has received numerous honors and awards in recognition of her overwhelming generosity and support, including induction into the OSU Hall of Fame and the OSU Spears School of Business Hall of Fame, receiving an OSU Honorary Doctor of Letters degree, being named Philanthropist of the Year by Women for OSU and and recently joining the Doel Reed Center Advisory Committee.
Greenwood and her husband, Michael, have served their alma mater in countless way, playing key roles in several major facility updates on the OSU campus, including the Edmon Low Library’s Anne Morris Greenwood Reading Room, Wesley Center Student

Activity Hall, Greenwood Center for Online Excellence, Greenwood Tennis Center, The McKnight Center for the Performing Arts and the Greenwood School of Music.
The Greenwoods believe every student should have access to higher education and have supported numerous scholarships spanning all disciplines of study, as well.
Oklahoma State University announced the appointment of Dr. Ann Bluntzer as the executive director of the Hamm Institute for American Energy in July. Bluntzer previously was the executive director of the Ralph Lowe Energy Institute within the Neeley School of Business at Texas Christian University.
Hamm Institute founder Harold Hamm called Bluntzer an extraordinarily talented leader who will continue to build the Hamm Institute for American Energy as it tackles the world’s greatest energy challenges and works to secure America’s energy future.
“The Hamm Institute for American Energy was created to inspire the next generation of clean, affordable, reliable and responsibly produced energy for humanity’s growing energy needs. Dr. Bluntzer is just the right person
This spring, Oklahoma State University Director of Athletics Chad Weiberg announced wrestling great David Taylor as the eighth head coach in OSU history.
“With 34 national championships, the Oklahoma State wrestling program is the most successful in the country by any metric, regardless of sport. We began this search knowing there is no goal that is unattainable for Cowboy wrestling. No expectations are too high,” Weiberg said.
Taylor — an Olympic gold medalist, three-time winner at the World Championships, two-time Dan Hodge Trophy winner, two-time NCAA champion, four-time NCAA finalist and four-time Big Ten champion — holds

to lead the way. She will develop the future leaders in American energy and advance the mission of this institute for the benefit of America and its allies,” Hamm said.
Bluntzer’s expertise in energy, agriculture and business, along with OSU’s land-grant mission, will uniquely position the Hamm Institute for American Energy as the preeminent institute for common-sense energy solutions for the world.

one of the most impressive résumés of any wrestler in history.
“It’s an honor to be in this position and I’m extremely grateful,” Taylor said. “I’m looking forward to the future of Oklahoma State wrestling. It has an unbelievable tradition and I’m excited to be part of it moving forward. I’ve achieved everything I have wanted
OSU President Kayse Shrum said Bluntzer will help the university advance its land-grant mission to serve the state of Oklahoma and beyond.
“Dr. Bluntzer’s experience and vision will propel the Hamm Institute for American Energy as it works at the crossroads of American energy security, energy innovation and the advancement of new technologies to meet global demand,” Dr. Shrum said. “The institute brings together the brightest minds and future energy sector leaders from around the world, and Ann’s energy sector leadership and educational background in agriculture make her a great fit to lead this work with Oklahoma State University.”
Bluntzer has a doctorate degree from the University of South Carolina and master’s and bachelor’s degrees from Texas A&M University. Additionally, she earned a business certificate in Sustainable Business Strategy from Harvard University.
A native of Glen Rose, Texas, Bluntzer is active in many civic organizations, including 4-H and Girl Scouts, and is also active in global energy and agricultural organizations.
in my personal career, and this is no longer about me. I am just thrilled to be in the position to help others achieve their goals, and truly make an impact in the wrestling world and on the lives around me.”
As a Penn State wrestler from 2009-14, Taylor put together a record of 134-3, totaling 50 pins, 42 technical falls and 29 major decisions on his way to earning the 2012 and 2014 NCAA titles at 165 pounds. At the world level, Taylor most recently won his fourth World/Olympic gold medal at 86 kilograms in 2023, dominating the field. He went 5-0 at the event and pinned Iran’s Hassan Yazdani in the world title bout, leading 9-3 at the time of the fall. The five wins included three falls and two technical falls.
Prior to that, he won gold at the 2020 Tokyo Olympics that were held in 2021, as well as world titles in 2022 and 2018 to go with a world silver medal in 2021.
Oklahoma State University has earned a 5 Star rating in the latest QS Stars ratings, announced by higher education analyst QS — Quacquarelli Symonds.
This achievement recognizes OSU as a world-class institution for its excellence in the required categories: teaching, employability and internationalization.
The QS Stars university rating system is an internationally recognized mark of quality, which provides a comprehensive framework to rate and compare universities’ performance across a broad spectrum of criteria.
OSU earned a 5 Star rating in the learning environment category, which was evaluated based on teaching indicators like faculty-student ratio, student satisfaction, retention rates and learning management system effectiveness. They also assessed sports facilities, library resources, campus amenities, medical services and student society availability.
QS Stars evaluated employability through aspects such as employer reputation, graduate employment
Oklahoma State University is one of just 25 institutions to earn the inaugural Carnegie Elective Classification for Leadership for Public Purpose.
The distinction, which was recently awarded by the American Council on Education, the Carnegie Foundation for the Advancement of Teaching and the Doerr Institute for New Leaders at

rate, employability outcomes, alumni impact, career support, apprenticeships and internships, giving OSU a 5 Star rating.
As a complex, multi-campus R1 research university, OSU’s faculty participate in groundbreaking research that makes an impact worldwide. QS measured OSU’s research quality papers per faculty, citations per paper, research funds and academic reputation and awarded a 5 Star rating.
In terms of new grant dollars awarded, three-fourths of the way into FY2024, OSU has nearly matched the entirety of FY2023. To be specific, new grant dollars awarded as of March 31,
Rice University, recognizes institutions that intentionally cultivate leadership abilities among students, faculty and staff.
“OSU is the only land-grant institution and one of three Big 12 members to receive the recognition, which is a reflection of OSU’s commitment to tackling complex societal issues and a deeper understanding of leadership as a public good,” said Senior Vice President and Chief of Staff Jerome Loughridge.
OSU Provost and Senior Vice President Jeanette Mendez emphasized the university has always been firmly committed to building principled leaders.
$70.9M, came to 96.3% of FY2023’s full-year total, $73.6M.
OSU earned a 5 Star rating in the internationalization category, which assessed the institution’s international student and staff population, the diversity of nationalities among students, and the extent of its global university partnerships.
OSU hosts students from over 100 countries and all 50 states. In 2023, the university established its sole international office, OSU-Mexico, serving as a central hub for exchange programs, recruitment, study abroad initiatives, and partnership building.
“Our focus is on empowering our students to become ideal graduates and supporting our faculty and staff to best serve students while continuing to elevate OSU as the nation’s premier, modern land-grant university,” Mendez said. “On behalf of OSU, I would like to thank the American Council on Education, the Carnegie Foundation for the Advancement of Teaching and the Doerr Institute for New Leaders for recognizing our university with such a high honor.”
OSU showed excellent alignment among campus mission, culture, leadership, resources and practices supporting dynamic and noteworthy public leadership.

OSU alumnus uses athletic background to change his life
In 2009, Shadrack Kipchirchir dreamed as big as the sky and took a risk for his future.
The Kenya native decided he wanted to attend college in the United States.
“My brother was already in the U.S., and he told me, ‘If you want to go to college in America, be good in school and get a sports scholarship,’” Kipchirchir said. “In 2009, I worked hard to get good grades at school, and I did some small training. In 2010, I qualified to get a full ride at Western Kentucky University.”
Kipchirchir ran for Western Kentucky for a year and a half, receiving All-American honors as one of the top freshmen cross-country runners in the
nation. In 2011, Kipchirchir decided to transfer to Oklahoma State University.
“I visited Stillwater and loved the environment,” Kipchirchir said. “OSU had a great atmosphere for both school and running. I loved the small town. Plus, the team and coaches were amazing.”
Kipchirchir attended OSU, majoring in construction management technology until he graduated in 2014. While running for OSU, he received guidance and mentorship from track and cross-country coach Dave Smith.
“He was a great team guy and into the team experience,” Smith said. “He’s a natural leader, a great athlete and student with a very kind and
gentle personality. He was easy to get along with and extremely popular amongst his teammates because of his personality.”
Competing in indoor track his senior year, Kipchirchir earned an AllBig 12 honor with a runner-up finish in the 3,000-meter race and placed 11th in the 5,000-meter at the NCAA Championships to earn second-team All-American honors.
“I think becoming a good distance runner takes time,” Smith said. “In our program, we do things for the future, for getting athletes to where they want to go, which can mean taking it slow to start. Shadrack’s lifetime running experience was about two years, so it took time to grow athletically. He is very gifted with a natural skill for distance running.”
In cross-country, he helped lead OSU to Big 12 and NCAA titles and finished with his career-best time at nationals, placing 18th to earn All-American recognition. He took third at the Big 12 Championships to secure All-Big 12 honors.
In addition to investing in his running, Kipchirchir was determined to be diligent in his studies and receive a quality education. At the Big 12 Championship, he earned recognition as a first-team Academic All-Big 12 honoree and a USTFCCCA AllAcademic performer.
“He was very focused on academics and always saw his degree in construction management as his path to a better future,” Smith said. “Which he still sees it that way, but he realized if he could get to a certain level in running, there would be an avenue for him as a professional runner. There was then motivation behind his dream, giving him something to dream about.”
After graduating from OSU, Kipchirchir decided to join the military in 2014. He said he saw how inspiring the military was while watching his younger brother graduate basic training.
“My brother graduated a changed man,” Kipchirchir said. “The way he talks, the way he thinks, even the way he told me to do things. That’s when I decided I
wanted to be a soldier and hoped they would support my running.”
Kipchirchir qualified to join the World Class Athlete Program after his enlistment in 2014. Following basic training, he received his citizenship in 2015 and has continued to run for the U.S. In 2016, Kipchirchir represented Team USA in the Rio Olympics.
Now in his running career, Kipchirchir has transitioned to competing in marathons and is working to qualify to run for Team USA in the 2028 Olympics. After his running career ends, he wants to return to his degree and pursue a career in real estate. He also hopes to mentor younger runners to help other athletes achieve their dreams.
“We are focused on the long-term development of student-athletes,” Smith said. “If an athlete is trained correctly, unlike other sports, athletes in long distance usually perform their best at 25 to 27 years old. When I started coaching, I made a deal with myself to focus on getting our athletes to their final peak, being the best they can be.”

time at nationals, placing 18th to earn
WE ARE CAREER BUILDERS. WE ARE TECH INNOVATORS.





Progress continues on the new Veterans Hospital in downtown Tulsa, and OSU Center for Health Sciences is proud to be part of this ambitious project to improve the quality of care for veterans in our state. In August, we marked 50% of construction completion with a “topping out” celebration that included city, county, state and federal officials along with partners from the veterans administration, local philanthropy and others.
We look forward to the completion of this tremendous project in fall 2025 and making an impact on the health of Oklahoma’s veterans.
The Women for OSU Endowed Scholarship is a prestigious award that recognizes academic, philanthropic and volunteer activities among Oklahoma State University's students. Women for OSU awards annual scholarships to students who are passionate about making a positive impact in the world around them.
For more information on donating, visit OSUgiving.com/women


Hometown: Tahlequah, Oklahoma
Major: Doctor of Osteopathic Medicine
Describe a person or experience that shaped who you are today.
A person who has shaped who I am today is my grandmother. She has always served as an example of inclusion. I grew up with a large family that welcomed others to experience life with us. An example is a foreign exchange student my dad’s family hosted when he was in high school who is now considered one of my “aunts” and is included in family pictures. No matter the person or their background, my grandmother always found an extra place at the dinner table or an extra “sock” (stocking) for Christmas. I aspire to be as inclusive and welcoming as she has been.
How have scholarships impacted your time in college?
Scholarships are not only affirming, but they help with the very real challenge of finding ways to pay for school. Loans come with interest and often force people into taking jobs that pay more to help relieve that burden. With less loans, I can pay off this debt more quickly and focus on work that I care about, which is helping underserved populations both in the U.S. and internationally.
What would you say to the donors who made your scholarship possible, if given the chance?
I would offer a sincere and heartfelt thank you. It is inspiring and appreciated to know that there are people willing to help others. I know that when I start earning an income, I plan to help others as I have been helped. I hope the donors know that their scholarship is not only helping me, but others in the future.


Hometown: Muskogee, Oklahoma
Major: Sociology: Criminology/Criminal Sciences
Describe a person or experience that shaped who you are today.
The people who have most profoundly shaped the individual I am today are undeniably my parents. My father's journey from Queretaro, Mexico, to the United States exemplifies unwavering determination and resilience. His commitment to giving back to his community has deeply influenced my own aspirations to positively impact those around me. Equally influential is my mother, a dedicated teacher whose unwavering support and encouragement have been the bedrock of my life. Her intellect, compassion and selflessness are qualities I aspire to emulate daily. Together, my parents have instilled in me the core values of compassion and resilience that guide my actions and decisions.
What does receiving a Women for OSU scholarship mean to you?
Receiving the Women for OSU scholarship holds profound significance for me as it allows me to continue to pursue my degree in sociology with a concentration in criminal justice. This scholarship has given me an amazing opportunity to deepen my academic studies and has helped relieve me from financial burdens.
What would you say to the donors who made your scholarship possible, if given the chance?
I would express my profound gratitude for their generosity and the incredible opportunity they've provided. Their support means the world to me, and I am deeply thankful for their contributions.
Hometown: Richmond, Indiana
Major: Biochemistry and Molecular Biology
Describe a person or experience that shaped who you are today.
A person who has shaped who I am today is my grandmother, Janet Seals. She has been a role model and a woman I look up to, as she exemplifies resiliency and optimism. My grandmother has had multiple sclerosis for the entirety of my life, but she still chooses to see the good in each day rather than dwell on the setbacks. She has truly taught me how to enjoy the small things in life and continue moving forward no matter the circumstance.
How have scholarships impacted your time in college?
Scholarships have impacted my college experience in several aspects, spanning from financial opportunity to personal and leadership development. The most significant impact from scholarships is their capacity to offer others' trust and faith in me to continue working towards my aspirations and making those aspirations financially viable as well.
What would you say to the donors who made your scholarship possible, if given the chance?
I truly cannot thank the donors enough because they have not only made it possible for me to continue my education at OSU, but they have also granted me the opportunity to eagerly work toward my future with the trust that I will reach where I am meant to be. I would like to express my gratitude for those with deep passion for OSU who continue reinvesting into younger generations. Their generosity continues to grow the Cowboy family with loyalty and integrity, which is a philanthropic movement I aim to join one day as well.

OSU Online is ranked #1 “Best Online College in Oklahoma” by

Continue your Cowboy legacy at Oklahoma State University with a flexible and affordable online graduate degree or certificate. With career-ready options in high-demand fields and access to student support services, it’s easy to see why OSU Online is ranked as the #1 “Best Online College in Oklahoma.” Apply today and receive waived application fees for our OSU alumni and, for the first time, one rate tuition for most degree programs!*
Set yourself apart with a DBA from the Spears School of Business.
Delivered in a hybrid format, this intensive 3-year program is tailored to meet executives’ demanding schedules with synchronous online classes and monthly in-person residencies. It is designed to develop innovative, evidence-based leaders by applying research methods to solve complex business problems. Graduates will return to their organizations better equipped to lead and direct strategic initiatives in today’s fast-paced environment.
Now accepting applications for Fall 2025.


It was 6:30 p.m. on Friday, June 18, 1954, when Abe Lee Hesser stepped out of Student Union Parlors A, B and C into the hallway looking for the guest of honor, who was half an hour late.
Three hundred local, state and national dignitaries were seated inside at the most prestigious dinner to date on the Oklahoma Agricultural and Mechanical College campus. Hesser, only 29, had been named director of the Student Union the year before.

Coming down the hallway was the diminutive, welldressed man he had been looking for. The two men spoke briefly; Hesser then opened the door to the dining hall and made the required formal introduction: “His Majesty, the King!”
Every attendee stood up as Emperor Haile Selassie walked past Hesser and glanced at Hesser, expressing appreciation but slight consternation. His official title for formal introductions was “By the Conquering Lion of the Tribe of Judah, His Imperial Majesty Haile Selassie I, King of Kings, Lord of Lords, Elect of God.” It could be abbreviated as His Imperial Majesty Haile Selassie in an emergency. Because the task had not been assigned earlier, Hesser, unaware of the protocol, had done the best he could on short notice. There were very few lapses in protocol during Selassie’s visit to Stillwater that summer. The college administration had been coordinating diplomatic protocol efforts with the U.S. Department of State for six months after the emperor made his announcement
regarding a trip to several American locations, including OAMC.

Emperor Haile Selassie
Years earlier, President Franklin D. Roosevelt invited Selassie to the United States. President Harry S. Truman initiated the Point Four Program, which brought OAMC President Henry Bennett in contact with Selassie a second time in May 1951. President Dwight D. Eisenhower had renewed the invitation to the emperor when he was inaugurated in 1953. The official state visit was announced on Jan. 12, 1954.
Having never prepared for a royal visit, OAMC administrators reached out to national officials with experience in formal affairs. After contacting



It was a warm, sunny afternoon in mid-June when a crowd of over 1,000 Oklahoma citizens gathered at Searcy Field Airport in
the State Department for guidance in March 1954, OAMC President Oliver Willham sent a letter of invitation to Selassie’s private secretary, Tafara Worq, extending a formal request for the imperial entourage to visit Stillwater and the college.
The correspondence included several dates during Selassie’s travels and suggested various activities at OAMC. Willham contacted OAMC faculty member Clarence. L. “Dutch” Angerer, dean of the newly established Imperial Ethiopian College of Agriculture and Mechanical Arts, who had provided a more detailed itinerary for Selassie’s trip abroad and included information on the appropriate channels for contacting the imperial household.
M.C. Berger from the State Department provided a draft letter, and Willham utilized her suggestions in his correspondence with Worq. Copies of Willham’s letter were also forwarded to the U.S. ambassador in Ethiopia, Joseph Simonson, and the Ethiopian ambassador to the U.S. in Washington, D.C.
Willham also corresponded with Dr. Luther Brannon, OAMC faculty member and associate director for Agricultural Extension, who was in Addis Ababa heading the Ethiopian A&M College. Brannon had an extended meeting with Selassie in April and provided his detailed notes to Willham highlighting specific agenda items for the OAMC administration to consider addressing during the campus visit. Simonson sent Willham a four-page memo providing detailed but brief biographies of the imperial entourage. It included a
phonetic spelling of their names, titles, how they were to be addressed, ages, hobbies and interests, educational backgrounds, marital status, children, languages spoken and relevant experiences.
Selassie planned to be in Stillwater for 19 hours, starting with his 3 p.m. arrival at the airport in a specially reserved Trans-World Airline Constellation named the “Star of Bombay,” used throughout his extended trip. An airport ceremony, brief tours, dinner and reception would occur on Friday. Breakfast, additional tours and a parade down Main Street were scheduled for Saturday morning before his departure time of 10 a.m. Logistics were planned and coordinated to transport the emperor, his entourage
Selassie exited the plane onto the boarding stairs leading down the tarmac. He smiled, then raised his right hand to salute the crowd and slapped his left leg with a swagger stick as they welcomed him with applause.



and baggage to the Student Union Hotel. The Presidential Suite on the third floor was reserved with the rest of the group, security and dignitaries staying in the remaining third- and fourth-floor rooms in the Student Union.
The official list of arriving guests changed frequently and adjustments were made quickly with accommodations. Campus and Stillwater police departments were instrumental in supporting the movement of the entire ensemble, providing parking and other security arrangements.
Formal attire was required for those attending the dinner and reception. For men, this meant tuxedos or white dinner jackets. Stillwater clothing stores and local men’s wear merchants providing tuxedo rentals were overwhelmed. Male guests traveled to Oklahoma City, Norman and Tulsa to acquire the proper apparel. Women were to wear formal dresses either “ballerina” style or full length.
Before arriving in Stillwater, Selassie attended a White House dinner, appeared in a New York City ticker tape parade, visited cities and colleges in the U.S. and Canada, where he received several honorary degrees and attended a New York Yankees baseball game as manager Casey Stengel’s official guest.
Before leaving the U.S. for Mexico, the entourage added the one-day OAMC stop to their itinerary.
Selassie’s flight had been delayed slightly coming from California when the emperor requested that the pilots fly a loop around the Grand Canyon.
Ethiopian and American flags waved in the breeze as the OAMC band was there for the brief following ceremonies. National, state, city and college officials all provided brief remarks. Selassie had informed the campus earlier that he would like to be introduced to an American Indian. The college invited Acee Blue Eagle to join the welcoming committee program. Blue Eagle was a member of the Muscogee
Creek Nation and had talents as an educator, dancer, musician and artist. Dressed in Native American regalia, Blue Eagle christened Selassie as the Great Buffalo High Chief, his son, Prince Sahle Selassie, as Thunder Eagle and granddaughter Princess Sebla Desta as Princess Morning Star.
A variety of vehicles formed a caravan to transport the guests and their luggage to campus. After a brief tour of the new air-conditioned library, the official party arrived at the Student Union for check-in at 5 p.m. Only an hour was allowed to relax and change into formal attire for the dinner at 6 p.m.
When the emperor arrived and was ushered in with Hesser’s announcement, the five-course dinner began. Gov. Johnston Murray spoke, as did Dr. Willham and Dr. Albert E. Darrow, OAMC vice president for agriculture.
Many attendees were invited to attend the reception in the Student Union Ballroom. The guest list was nine pages long, single-spaced, with two columns per page. Another page was allocated for press, radio and television guest invitations. All college staff were invited to the reception. Interested employees needed to visit the President’s Office to pick up their official invitation and personal admission card. All 1,600 who requested an invitation were there.
Divided into two groups of 800, the first group was admitted at 8 p.m. and the second at 9 p.m. The reception lasted until almost 11 p.m. Only 20 minutes had been allocated, with each group to meet Selassie in a receiving line with the Williams and

the Murrays. The emperor insisted that all those attending have an opportunity to meet him stating, “The people who came here should be greeted.” He stood with the two couples greeting guests in the receiving line for two hours and 20 minutes.
“I am very glad indeed to be present with you,” Selassie said in a speech. “Indeed, I have made an exception to my usual practice on this trip in leaving my itinerary entirely and making this 2,000-mile trip to express to you my deep appreciation for all that Oklahoma A&M has done and is doing to technical assistance to Ethiopia.”
As the evening was winding down, the emperor returned to the president’s suite and spent meaningful moments with Henry and Vera Bennett’s children and grandchildren.
Selassie had promised Dr. Bennett before his death that he would visit Stillwater and OAMC to strengthen the Ethiopian bonds with the campus. Selassie reserved this special time with Bennett’s surviving family to share his appreciation for what their father had done for Ethiopia.
While his father was with the Bennett family, Prince Sahle enjoyed the Student Union jukebox, eating hot dogs that he found “tasty,” savoring ice cream sundaes and Cokes with new acquaintances. Most guests had retired to their rooms by midnight, but at 2:30 a.m., Saturday morning, Selassie notified the guard at his door that he needed medical assistance. His stomach was upset, and he was unable to sleep. Craig Hampton, head of the Student


Union Hotel, contacted Stillwater physician Dr. George Gathers.
“He was pretty uncomfortable when I got there but was feeling much better by the time I left an hour later,” Gathers said.
Selassie was given opiates and sulfa drugs, encouraged to eat a light breakfast and get more rest. For his early morning excursion, Gathers was presented with a gold medallion commemorating Selassie’s coronation.
The president of Mexico notified the emperor’s staff that he would like them to arrive in Mexico City earlier than initially planned. After his challenging night with little sleep, the emperor hoped to have time to relax on the flight south. The parade down Main Street was canceled, and the campus motor tour was altered to include only a quick trip through the Oklahoma Agricultural Experiment Station west of town as they made their way to the Stillwater airport.
A few complimentary remarks were made, and at 7:46 a.m., the Ethiopian visitors were on their way to Mexico. Melvin B. Tolson, the first Black graduate student to complete his
coursework at OAMC and a Langston University faculty member, had hoped to present a book of poems and prose titled “Rendezvous with America.” The earlier-than-expected flight prevented their meeting, and the book was sent later to Selassie.
In July, Simonson wrote to Willham from Addis Ababa.
“How tremendously pleased all of us were over the marvelous way in which you handled the visit of His Imperial Majesty on your campus and in your community and state,” Simonson said.
“You all acted as though you were in the habit of entertaining royalty every week. I know that His Imperial Majesty appreciated so much the opportunity to be with you and the Oklahoma family.”
The emperor’s visit cemented the new academic relationship between OAMC and Ethiopia, enhancing the lives of hundreds of Oklahomans while providing educational and agricultural opportunities to tens of thousands of Selassie’s countrymen, known at Oklahoma State University as our “Great Adventure.”
*An asterisk designates life members who joined as OSU students.
Samuel Summers, '23
Addie Wagner*
Erik Inman*
Julie Bridges, '92
Aiden Shepherd*
Abby Welke*
Kathleen Prichard, '84
Will Krieg*
Samuel Anderson*
Janet Mickle, '68
Mckinzie Mcaffrey*
Kendall Syska*
Jimmy Burris, '94
Cleva Knecht*
Raven Fulks*
Cody Curry, '17
Bradley McCollough*
Brad Cox, '89
Corinne Kissel*
Milan Maselli*
Cooper Martin*
Victoria Allen*
Chanler Melton, '15
Austin Pittman*
Emma Grace Nowotny*
Allison Santimaw*
Debbie Wilson, '71, '80
Tami Deever, '76
Keltan Norris*
Amanda Benn, '06, '11
Andrew Geelen*
Erin Thompson*
Kathryn Coleman*
Wende Boles
Debra Miller, '82
Marleigh Smith*
Alyssa Arnold*
Chase Horsley*
Kirk Standridge, '79
Judith Thomas, '97
Rick Corley, '67
Don Enslow, '78
Bri Day*
Brad Anderson, '00
Addie Meziere, '23
Angela Davis*
Tricia Reese
Trinity McMahon*
John Osborn, '87
Sydney Speer*
Sydney Peach*
Jenni Cook, '12
Ragan Parkerson
Ryan Kuepfer, '23
Christopher Teague, '94
Sherri Hooker, '05
David Neely, '67
Rachel Morgan, '14
Tiffany Pasley, '93
Lily Meyer*
Campbell Edstrom*
Lindy Whorton, '90
Kirk Mills
Presley Montz*
Eva Webb*
Dylan Parks, '23
Rick Yeager, '78
Laura Hatch, '84
Ronald Due, '78
Jered Davidson, '09
Patricia McIntosh, '17
Margaret Ann Collins, '62
Jim Tempero, '65, '67
Nancy Beckstrom, '76, '80
Kayla Beenen*
Benjamin Wianecki*
Tristan Ball*
Gary Scammahorn, '74
Leslie Manzer, '65, '66, '74
Samuel Van Rhijn*
Kevin Flack*
Abbey Breuer*
Tonda Shelton, '88
Erryn Sciba*
Scott Stuart, '82
Sue Tanner, '66
Trellys Riley, '83, '87, '94
Lisa Reid*
Spencer Thurman*
Bill Womble, '71
Kaitlin Koons*
Jade Garrison
Trinity Grissom*
Cloie Bruce*
Andi Scaggs, '15, '22, '22
Addison Cobb*
Bill Manera, '66
Carson Kiser*
Frank Poeschel, '88
Tina Newton, '93, '97, '23
Chris Taylor, '04
Carlee Yoho*
Paul Terhune, '95
Chris Creider
Brian Ellerbeck, '84
Kimberly Burns, '22, '22, '22
Chris Weiszbrod, '20
Kenneth Kindley, '61
Abigail Cage*
Nelda Newman, '70
Faith Gatley*
Rachel Buford, '16, '18
Brad Marckx, '93
Richard Pidcock, '07
Zane Hilbig, '21
Melissa Lamprich, '70
Robbie German, '80
Caitlin Dreher, '22
Brooks Benson*
Beverly Shannon, '79
Stephanie Brown, '00
Abie Koch*
Lisa Diel, '78
Corbin Steele*
Ashlee Torres*
Mary Lynn Wright, '83
Macie Naugher*
Deborah Sellers, '73
Linda Berger, '97
Ed Rodgers, '76
Luke Hilton*
Laura Steen, '05
Raeden Schon*
Lauren Bergman*
Rich Reese, '82
Owen Piersall*
James Pilkington III, '23
Gwen Martin
Stephanie Young, '98
Kelli Black, '00
Paul Welch, '77, '81
Thomas Fucci*
Trace Liles*
Darrell White Jr., '72
Carma Jean Ealom, '11
Laxman Ganesan, '97
Amanda Upchurch, '03
Don Pitts, '75, '03
Hailey Walters*
Elijah Vice*
Kawai Porter, '22, '22
Jared Leon, '23
Ellie Franks*
Layne Brewer, '82
Elyssa Teel*
Amie Gates, '01
Gabe Tiefenthaler, '23, '23
Shirley Wagner, '74
Hannah Jones*
Philip Middleton, '59
Parker Birdsong*
Kevin Vann, '93
Katherine Landers, '14, '18
Lillie Kirby*
Melinda Aufleger, '81
Kenneth Owen, '75
Ethan Boyer*
Michael Stanton, '73
Aimee Odom*
Hunter Thomason*
Brittany Woods, '22
Zachary Burrow, '11
Valerie Lusk, '03
Bill Jackson, '55
Alexa Troutman*
Katelyn Leibhart, '23
Lindsey Jones, '21, '21
Austin Sawyer*
Susan Teague, '94
Kelsey Hulcher*
Jackson Silvey*
Aiden Minton*
Scott Tyler, '85, '85
Kyle Huckaba, '84
Shelby Jennings, '23
Bob Kilpatrick, '84
Brock Bennett, '23
Cade Bernard*
Holly Eaton
Jay Cruse, '73
Alexander Jones*
Sean Cude*
Natalie Anderson*
Jacie Ross, '17, '23
Zoe Hester*
Tom Fehrle, '57, '63
Ismail Adawi, '79
Scott Hatch, '85
Erin Crawford, '03
Kindra Vaden, '94
Nick Patel*
Justin Snook*
Dakota Whitman*
Mary Reneau, '73
Savanna Buntin*
Randall Rogers, '79
Jacob Witthuhn*
Jade Jones*
John Chitwood Jr., '67, '69
Christopher Worch, '13
Joe Budzinsky, '76
Halle Wilson*
Kris Matthews, '11
Naomi Boozer*
Lisa Strealy, '92
Ann Talley, '73
Misty Davis
Mackensey Doyle*
Gordon Schein, '58
Carmen Young, '21
Alexis Marroquin, '20, '22
Larry Cagle, '72
Tracy Anthony, '87
Troy Thompson, '97, '00
Nathan Franklin*
Freda Park
Mark Sellers, '73
Nicholas Flatt*
Serena Gray*
Brooke Bohanon*
Conner Steen, '06
Steven Cholity, '23
Bailee Arthur*
Mason Hearn, '22
Erin Slagell*
Blake Bryant, '23
Karson Matthews, '22
Jennifer Fenton, '91
Rosalie LeMay*
Taylor Gibson*
Huntyr Terry, '23
Greg Seay, '92
Catie Scott, '08
Buddha Courtney, '84
Cecilia Woods, '94
Jayke Ratliff, '22
Angela Baker, '07, '08
Lawrence Lamprich, '69, '71
Matthew Caves, '97
Kaitlynn Withers*
Edward Bridges, '84
David Collins, '66, '71
Sydney Osmus*
Matthew Murphy*
Rochelle Covington, '05
Elana Grissom, '83, '93, '13
Hannah Britt, '23
Abigail Teal*
Ainsley McFarlin*
Tara Bartley*
Joanne Smith
Cheyenne Wood*
Cameron Shropshire, '23
Leslie Rodriguez Ruiz*
Steve Armbruster, '67, '70
Shaylee Manwell, '23
Kassidy DeForest*
Mackenna Davison*
Linda Roberts, '83
Bill Bryan*
Nancy Morgan, '76
Heather Spears, '05
Randi Laverty*
Logan Kelley*
Lisa Wingate, '88
Michelle Stewart, '22
Mitchell Nickles*
Victoria Tortolero, '02, '03
Marie Due, '82
Pressly Morrison*
Trey Lack III, '09
Maggie Landers*
Sandra Jensen, '70
Austin McKay*
Teresa White, '83
Ellen Stevens, '93
Pat Mickle, '69
Carolina Couch*
Sarah Welch, '78
Sue Rehm-Blankenship, '70
Todd Duncan, '78
Mariah Martin*
Steve Streeter, '90
Torin Enevoldsen*
Emma Tarantino*
David Koenig, '84, '84
Gina Hayes, '95
Lori Weyhrich, '91, '93
Kaylie Sequira*
Larry Janssen, '74
Colby Fuser, '00
Taylor Buice*
Cinda Rodgers, '79
Bryce Smith*
Kirstin Kakacek*
Patty Armbruster
Joey Madison
Thomas Pinsky*
Brad Uhlenhake, '00
Jennifer Gibson, '91
Nessa Washam*
Robert Triplett IV, '23
John Billingham, '71
Toni Wetmore*
Sydney Clopton*
Samuel Buford*
Aspen Swaim*
Stacie Paciotti, '89
Jace James*
Nicholas Johnson*
Chris Smith, '77
Ethan Crook*
Katie Walters, '09
Dalton Faires, '23, '23
Ian Thomas*
Logan Stephens, '23
Alisa Frank*
Mary Green*
Rolland Wagner, '73
Samuel Many*
Michael Jones
Cecil Stone, '59
Sherrie Armstrong, '11, '13
All new Life Members receive a kit filled with exclusive items for the most loyal and true Cowboys.
Peyton Patterson*
Kelley Vogt, '75
Rhonda Davis
Lewis Simms, '66, '68
Belle Wood*
Ryan Cole, '01, '05, '11
Amelia Imotichey*
Carolyn Clifton, '76
Darcy Golla*
Jennifer Hankins
Kenneth Burch, '86
Linda Stumpff, '82
Audrey Webber, '86
Kyndal Hinton*
Alli Garcia*
Chuck Creider, '84
Gigi Mello Henrique, '23
Lucas Lee*
Molly Keller, '74, '76
Sam Wingate, '88
Lisa Kubik, '83
Sara Kopp*
Sarah Easterly*
Michael McDaniel*
Shaeffer Suttle*
Emily Bevill*
Don Hinkle, '69
Jenna Curry*
Cara York*
Riley Laplante*
Tessa Tronzano*
Lexie Austin*
Brooke Miller*
Saundra Manzer
Elese Kerr*
DeAnn Mankin, '78
Zachery Foster, '20
MacKenzie Darris, '19
Abby Hester*
Kym Cowart, '83
Linda Cox, '70, '75
Kiley Benes, '02
Sherry Gullett, '73
Jason Poore, '22
Kj Briggs*
Everett Stallcop, '76
Deborah Dage, '86
Jayden Roybal*
Michael Forhan*
Mollie Godwin, '01
CaLyxx Griffin Tice
Jennifer Patterson, '02
Jenny Lindsey, '04, '07
Randy Heflin, '80, '81
Carsen Crowe*
Jacob Storts, '23
Sydney Vieira*
Adonis Gardner*
Melinda Carver, '73





Few people understand being a part of the Cowboy family more than twin sisters Twauna and Shauna Williams.
“The Cowboy family means community to me,” Shauna said. “My hometown, my tribal community and OSU are a part of that for me. Also, the extension through alumni, students, everything; just being a part of that community and having that sense of belonging to something.”
Originally from Smithville, Oklahoma, a small town in northern McCurtain County, the Williamses knew from an early age they wanted to attend Oklahoma State University. After graduating from Smithville High School in 2003, the sisters attended Eastern Oklahoma State College in Wilburton until they transferred to OSU in 2005.
While on campus, Twauna and Shauna were involved in the Native
American Student Association. The two credit their time attending events and getting to know other Native students as what sparked their interests to work in tribal affairs and get involved with the American Indian OSU Alumni Society.
“I think one of my favorite memories is the first OSU Powwow I went to as a student,” Shauna said. “It was an awesome experience and celebration of culture. With the rich cultural heritage we have in Oklahoma, to be a college student and able to attend and then to eventually return as an alumnus was so special.”
The two sisters graduated in 2008 with bachelor’s degrees in business. Today, in their professional careers, Twauna and Shauna both work for the Choctaw Nation of Oklahoma. To stay connected with their alma mater, the two both hold leadership roles
within the American Indian OSU Alumni Society. Twauna is the current president and Shauna is the incoming president, taking over for her sister for the 2024-25 term.
“Any time an alumnus has an opportunity to broaden their horizon, build their network and widen their community, I think they should take advantage of it,” Twauna said. “The American Indian OSU Alumni Society is a small but mighty network of Cowboys who are willing to help support each other and share different opportunities across the state.”
AMERICAN INDIAN OSU ALUMNI SOCIETY BY THE NUMBERS
12,246 ALUMNI AND FRIENDS
979 MEMBERS


A group of North Texas Cowgirls meet for an evening of networking and conversations at The

Members of the Cowboy family meet at Oak Tree Golf and Country Club in Edmond, Oklahoma, for the OKC Metro Alumni Chapter Golf Tournament. The annual tournament is held to raise money for scholarships for local students.



Members of the Cowboy family meet at Cascades Country Club in Tyler, Texas, for An Orange Occasion. The annual event is held to celebrate all things OSU and recognize local incoming OSU students.

Over 550 grandparents and legacies in attendance at Grandparent University participate in 22 different majors across two zoo-themed sessions.


Local Cowboys and Cowgirls from the Cherokee Strip compete against each other in a clay shooting tournament to raise money for scholarships for OSU students from the area.


Alumni from Cleveland/McClain Counties gather at Interurban in Norman, Oklahoma, for Networking and Social Hour.

Tom M. McDougal, ’61 premedical science, recently celebrated his 85th birthday. He is still working one half-day per week, golfing and exercising.

Edwin W. Thomas, ’65 accounting, has written two books, “Life Journey with God” and “Shoe Leather For Our Life Journey.” Thomas also started a website with free stories, audiobooks, podcasts and other resources.

Richard O. Litsey, ’69 English, retired from the U.S. Senate Finance Committee as counsel and senior advisor for American Indian Affairs and came out of retirement to serve as a presidential appointee for the Senior Executive Service with the Social Security Administration as director of the Office of Native American Partnerships. His duties included elevating the agency’s relationship with tribes and serving as the primary point of contact on tribal affairs by delivery of SSA’s services to retirees, people with disabilities and elders. Holding a law degree and master’s in law, he served over 35 years in federal service and has been married for 55 years to Elaine. They have two children, Brian and Meredith.

Patricia J. Dixon, ’75 recreation, gave a scholarship through the Sand Springs Community Theatre to Ivy Chronister, who will be coming to OSU in fall 2024.

William D. Walters, ’82 forestry, met fellow 1982 forestry graduates Gary Brannon, Dale Lenz and Walker Sandlin in New Mexico to renew old friendships made in Stillwater. They spent eight weeks during the summer of 1981 with other forestry students learning field techniques at Sipapu Ski Lodge in New Mexico. Their reunion trip included a visit to Smokey Bear’s grave site.

Chuck Bellatti, ’88 management, received an award from the Realtors Land Institute for being “Broker of the Year” in Agribusiness Land Sales of Region 8. Region 8 includes the entire state of Oklahoma and Texas.

Susanne Wasson, ’88 agricultural economics and accounting, was elected to serve as a member on the OSU Alumni Association Board of Directors. She is a senior commercial executive with 33 years of experience in the global agriculture industry.

George E. Surratt, ’89 electrical engineering, retired a year and a half ago, excited about his self-proclaimed “year of yes.” Currently, he’s juggling nonprofit boards focused on organ transplants, advising a fabulous performing arts center and helping his friend bring her awesome STEAM program for girls from New York to Minnesota.

Angela C. (McGowen) Barnard, ’94 agricultural economics and agribusiness, was promoted from facilities coordinator to director of facilities at Mississippi Children’s Museum. She is responsible for the care and maintenance of exhibits, facilities and grounds.

Jim Jawahar, ’94 doctorate in business administration, is releasing a new book, “Thrive! The Psychology Behind Achieving Professional Success.” It outlines eight pathways to achieve professional success while acknowledging that success may mean different things to different people and that the definition of success evolves with one’s career.

Jennifer (Norris) Gray, ’96 marketing, has twins who recently finished their first year in college. Her son plays collegiate lacrosse at Washington College, and her daughter attends Salisbury University, both in Maryland. While touring Salisbury, Gray and her daughter ran into a professor who had just finished speaking at OSU. Gray is actively involved in the Washington, D.C./ Maryland OSU Alumni Chapter.

Donald R. Helmer, ’96 political science, graduated from Langston University with his master’s degree in rehabilitation counseling. He passed the National Counselor’s Exam (NCE) and the Oklahoma Legal and Ethical Responsibilities Exam (OLERE) in November 2023. He continues to work for Community Bridges Inc. full time in Tulsa and Oklahoma City as a first responder for individuals who call the 988 Mental Health Crisis Line, but he is now also in private practice with Sassin and Associates, LLC in Tulsa, working with people of all ages helping them overcome their mental health challenges.

Laura (Shank) Sobiek, ’96, English, ’99 master’s in counseling and student development, lives in Columbia, Missouri, and works as a project coordinator for Continuous Quality Improvement at the MU School of Medicine.

Jonathan Dodson, ’03 finance, was elected to serve as a member on the OSU Alumni Association Board of Directors. He is a founding partner and CEO at Pivot Real Estate Development.

Jeromey A. Howard , ’05 sociology, is now serving as the general presbyter for the Presbytery of Wyoming as part of the Presbyterian Church.

Sheila S. Ferreira, ’05 journalism and broadcasting, returned to the Stillwater campus in November 2023, moving from the University of Tulsa to OSU and accepting the accounting specialist position at OSU Global.

Zach Burrow, ’11 construction engineering and management, was elected to serve as a member on the OSU Alumni Association Board of Directors. He is the managing member and director of Tulsa Operations at MillerTippens Construction.

Elizabeth A. Hoffman, ’13 management, her poem “Once Upon a Time When I Was Young” came in second place at the 2024 Tulsa Library 47 Annual Adult Creative Writing Contest. Hoffman said winning this award was exciting, and she is so thankful to have been a part of this year’s Adult Writing Contest.

Christian J. Cowart, ’14 business administration, joined Bell Nunnally as senior counsel. Thomson Reuters elected Cowart as a “Texas Rising Star” for 2022-23. Cowart is also a graduate of Baylor University School of Law.

Shelby I. Sever, ’15 strategic communications and ’18 master’s in education leadership studies, has recently overseen one residential camp facility, a branch of the YMCA of Northern Colorado. In March, they purchased a new mountain camp facility in Boulder, Colorado, that can oversee over 500 kids weekly during the summer. She oversees the construction, renovation and program build for the 300-acre property.

David W. Brewer, ’18, master’s in music, led the Regents Academy upper school concert choir at their performance at the large ensemble competition in Longview, Texas. They received an I - superior rating, placing first in their division. This was the first time this choir had ever performed in a choral competition.
Dorothy R. (Gage) Mayfield, ’58 fashion merchandising, and husband Gerry, ’58 electrical engineering, have lived in Connecticut for over 40 years. The two enjoy watching OSU sports on TV when able. They look forward to receiving STATE Magazine and learning about OSU updates.
Virginia Reeves, ’62 elementary education, launched her debut novel, “Once in the Blue Moon,” a story inspired by her childhood in Oklahoma. “Once in the Blue Moon” harks back to a simpler time of storytelling, with a classic theme of forgiveness, hope and the power of true love.
Douglas L. White, ’74 industrial engineering and management, has retired for seven years. White is active in Sugar Land volunteer organizations and the Zoning Board. He is also a Board Member of the LID Board and is very active in his church. He plays golf, rides many miles on his motorcycle and spends time enjoying his grandkids.
Robert D. Clinard, ’75 construction management, has been in his career for 50 years. He has been the contractor on various buildings: offices, first responder stations, churches, aircraft hangars, banks and many others.
Albert H. Wigchert, ’76 master’s in electrical engineering, retired on Labor Day 2023 from ATOS after a lengthy career in computer software development. He and his wife, Margaret, celebrated his retirement with a cruise to Alaska.
Mervin B. Deason, ’77 animal science, is exploring new breeds of cattle that have been introduced to the U.S. He is consulting and considering public speaking.
Larry P. McDowell, ’77 marketing, retired from Time Warner in 2014 after 34 years of service. After living in Houston for over 30 years raising his two daughters, he lives in Broken Arrow, Oklahoma. McDowell has three grandchildren from his oldest daughter, a high school academic dean in Texas. His youngest daughter works for Universal Studios in Orlando and was recently engaged on a Disney Cruise.
James C. Lefler, ’81 fire protection and safety tech, serves as president & CEO for JCL Service Company, which provides safety, process safety engineering, and material coordination services for oil and gas, refining, petrochemical and nuclear facilities around the globe.
Curt DeBerg, ’84 master’s in economics, ’85 Ph.D. in business administration, released a novel about Ernest Hemingway titled “Wrestling with Demons: In Search of the Real Ernest Hemingway.”
Ronald D. Peterson, ’84 political science and ’84 master’s in organization administration, is proud of his daughter, Ashley Peterson, for representing OSU as student body president and for graduating in four years.
Mark Kanady, ’86 marketing, and wife Deanna are both retired and enjoying the non-working world, traveling and a new lake house. They also have football season tickets and visit Stillwater frequently for games.
James C. Stark, ’86 marketing, is retiring in September 2024 after 33 years with Los Angeles County as a supervising attorney. His children, Garrett Stark, ’21 management, and Morgen Stark, ’21 strategic communications, left southern California to attend and graduate from OSU. In addition to retirement, Stark will move to the Dallas area for more time with his kids, golfing and traveling.
Lisa (Vereyken) Wingate, ’88 English, is a No. 1 New York Times bestselling author who released her 33rd novel, “SHELTERWOOD,” from Random House on June 4, 2024. Publishers Weekly gave the novel a starred review. Wingate is particularly excited about this book, as it is her first set entirely in Oklahoma. The story features scenes set on the OSU campus, and at a place the author remembers fondly from her days as a student, the Edmon Low Library. Lisa and her husband, Sam Wingate, ’88 animal science, enjoyed visiting OSU last fall for the Hall of Fame Ceremony and a library tour.
Godwin G. Dixon, ’89 management and wife Christa, now co-own two assisted living and memory care communities in Texas, named Teresa’s House after their business partner Teresa Whittington. Since they have been open, the communities have won “Best of Denton County” in Argyle and “Best of McKinney” every year. Both sites are currently being expanded, and they are planning a third site due to the demand for high-quality senior care.
James W. Joudrey, ’97 master’s in environmental science, has had many career changes: owning an environmental consulting firm, managing a powder coating start-up, sales manager for a chemical company and finally, an instructor at career colleges. He will always remember his OSU professors and their effect on his life. He is back in Stillwater after being away for many years.
Kenna Mitchell, ’97 journalism and broadcasting, received two awards from the American Association of State Highway Transportation Officials (AASHTO) Committee of Transportation Communications at its annual meeting in October 2023. The first award Mitchell received was for her role in the Video Production: Series category. The Dallas District team created multiple videos for TxDOT’s “End The Streak” safety campaign. Mitchell also received a highly coveted individual award called the “Spirit of Transcomm.” This award is given to one person nationally each year from a state transportation agency for demonstrating professionalism, expertise, strategic results, innovation and impact on identified audiences. In November 2023, TxDOT named Mitchell the agency’s Communicator of the Year for 2023. Mitchell has been with the Communications Division in the Dallas District since 2021.
Mark D. Callery, ’03 doctorate in osteopathic medicine, was recently awarded the National Population Health Pioneer Award for Physician Leader of the Year by CVS Accountable Care. This award was presented to Dr. Callery for his input on many accountable care organization initiatives. His contributions fostered new ideas, resurfaced best practices, and encouraged provider collaboration.
Caleb Rice, ’08 hospitality and tourism, has joined the sales team at Rancho Bernardo Inn (RBI) in San Diego as director of national accounts for the Mid-Atlantic and Northeast regions and Canada after almost 16 years with the illustrious Broadmoor in Colorado Springs, Colorado.
Nicole (Cabalo) Bowden, ’10 biochemistry and economics, finished her neurology residency at Sparrow Hospital/Michigan State University in June 2023 and moved back to Oklahoma. She is now a general neurology attending.
Sharyl L. Bickell is happy to announce that after 10 years as a franchise owner with Metro First Realty Unlimited, she has purchased a new franchise and has changed the agency name. Realty ONE Group Champion now serves the Stillwater and Oklahoma City real estate markets. They have 16 agents ready to help buyers and sellers with their most important asset.
Roy R. Lessly, ’81 doctorate in agricultural education, passed away on Feb. 13, 2024. Lessly was a professor in the OSU agriculture department. He finished his career as professor and head of the University of Tennessee-Knoxville Ag extension service. Lessly served as officer and president of FUTIAWA. He loved being an educator. He had an uncanny ability to make, create or fix anything without instructions or tools. Lessly served his country as a captain in the Air Force. He was awarded the Distinguished Flying Cross for his bravery and his ability to fix anything. He rewired a plane in flight, saving himself and the entire crew with only minutes to spare. He loved his family and many friends. He loved water skiing, going to the lake and traveling.

Clarence Worley, ’69 master’s in industrial engineering, passed away on March 1, 2024. He was born Aug. 14, 1936, in Bromide, Oklahoma, and graduated from Coalgate High School in 1954.

Upon graduation from Coalgate, he enrolled in a drafting course at Oklahoma A&M Tech. After graduating in 1955, Worley worked as a draftsman in Oklahoma City. On June 3, 1956, he married Mary Ann Giachino. In January 1957, he started college at Oklahoma City University, graduating in three years. While working full time for the Federal Aviation Administration in Oklahoma City, he completed a master’s degree in engineering at OSU in May 1969. Worley then moved to the Department of Defense in Huntsville, Alabama, for over seven years, where he received four Outstanding Performance Awards. After working for the DOD, he returned to the FAA, where he retired. Worley was very active in his church, St. Thomas More University Parish, where he served as a lector, greeter, communion minister and was a member of the Knights of Columbus. He was also very active in many civic duties in Norman, Oklahoma.

Brian Antal, ’22 MBA, and his wife, Allison, welcomed Lee Scott Antal into the world on June 15, 2023. He loves crawling, Mickey Mouse and rooting for the Cowboys.

Kinsey Garcia, administrative assistant in the Department of Brand Management, and her husband, Angel, welcomed Aiden Garcia on Feb. 16, 2024. Kinsey and Angel are excited for Aiden to be an OSU and Kansas City Chiefs fan.

Lundblade, ’18 business, and his wife, Heather, welcomed their daughter, Lillian

Jamie Schuermann, ’12 animal science and ’14 master’s agricultural communications, and Brent Schuermann, ’12 mechanical engineering technology, welcomed Beth Ruthann Schuermann into the world on Dec. 7, 2023, alongside 4-year-old brother Jace Aaron Schuermann.

Amanda Hamlett, ’16 sports media, and Heath Hamlett, ’14 general business, welcomed Harlee Maeve Hamlett into the world on March 5, 2024. Harlee joins her 4-year-old sister, Adley Mae, and was born ready to cheer on the Cowboys and Cowgirls. She enjoys watching OSU softball and cannot wait to go to her first Homecoming and attend OSU.

Kyndall L. (Smith) Whisenhunt, ’17 design, housing and merchandising, and Michael R. Whisenhunt , ’11 mechanical engineering, welcomed twins Harlow and Hudson Whisenhunt into the world on Jan. 11, 2024. The twins come from a long line of OSU graduates on both sides of their family.
Thomas H. Keller, ’89 secondary education, and Dr. Jeanie KlabzubaKeller, ’02 Doctor of Osteopathic Medicine, were married Oct. 7, 2023, in Edmond, Oklahoma.

Brenda E. Sweeney, ’80 animal science, celebrated the marriage of her daughter, Challie Sweeney ’13 education, on June 27, 2024, at the Spring in Edmond, Oklahoma.

Calvin H. Warner, ’14 philosophy, and Roslyn M. Dubberstein, ’15 liberal studies, were married at the Oklahoma City Golf and Country Club on May 18, 2024, with many Cowboys in attendance. Both Calvin and Roslyn are working as attorneys in Austin, Texas.



| 08.19.24
Late-breaking, record-breaking: As this issue of STATE went to press and the fall semester began, OSU reported record-setting freshman enrollment for the third consecutive year, surpassing the 5,000 mark for the first time. See the winter edition of STATE for in-depth coverage of this historic milestone.









